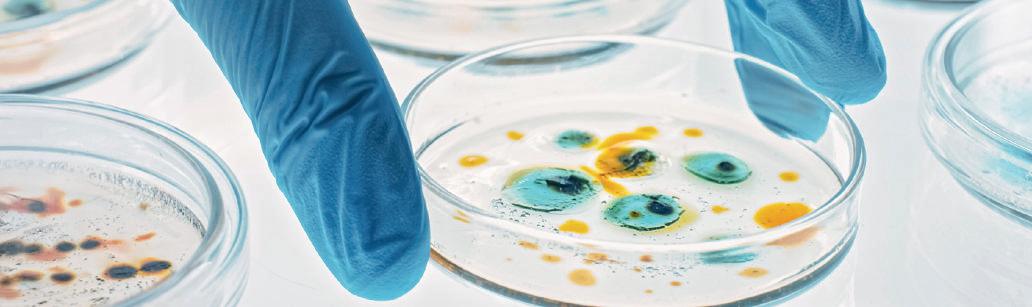

P2i™ protects moms and babies from toxic chemicals. Tested products – Trusted solutions
![]()

P2i™ protects moms and babies from toxic chemicals. Tested products – Trusted solutions
What is P2i™?
P2i™ is a doctor-led platform that helps protect mothers and children from preconception through age five by reducing toxic exposures, improving nutrition, and giving every child the best possible start in life. Our network of certified doctors uses easy, non-invasive CLIA-certified tests to measure toxicant levels and then guides families toward cleaner products and healthier lifestyle choices based on validated NIH science.
Mission
P2i bridges the knowledge gap about the impact of environmental exposures on the health of women and children, from preconception to infancy—and beyond.
Vision
The health of women and children depends on a healthy planet. Our vision is to advance environmental solutions that improve the health and well-being of women, children, families, and communities.
For Investors, P2i™ Offers an Extraordinary Opportunity.
Doing well by doing good.
Our $1B+ five-year target requires capturing just 0.2% of a $466B U.S.-addressable market across five proven revenue streams. With Direct-to-Consumer (DTC) wellness testing growing at 18.86% annually and our doctor network model generating $ 100,000-$ 150,000 per physician, this represents conservative execution in a high-growth sector.
Investors Snapshot:
$3M convertible note to reach cash-flow positive by Month 13 (funds product rollout, marketing, and early physician scaling)
15–200x returns potential (base to upside case)
$2–5B exit valuation at strategic acquisition or IPO
Multiple revenue streams (testing 40%+ margins, products 25–65%, database licensing $500M–$2B value)
Tax-efficient QSBS structure: Up to $15M capital gains exclusion if held 5+ years
The Problem is Real and Growing Chronic disease rates in children have exploded: More than one in three children now suffer from autism, ADHD, asthma, obesity, eczema, cancer or developmental delays. Pregnancy outcomes in America rank among the worst in the developed world. The National Institute of Environmental Health Sciences (NIEHS) states that the annual cost of environmentally related diseases in U.S. children is $76.6 billion.1
Root Cause
Environmental toxics (heavy metals, pesticides, endocrine disruptors), poor nutrition, and limited preventive care — most of it preventable.
Now is a Breakthrough Moment for P2i™
Three converging forces frame the P2i™ opportunity.
1. Scientific Consensus
NIEHS/EPA Children's Environmental Health and Disease Prevention Research Centers and the NIH landmark ECHO study ($350M+ research) followed mothers and children, supporting the link between toxic exposures, adverse pregnancy outcomes and children’s health. Validated test methods to measure the same toxicants are now commercially available.
2. Regulatory Pressure
Congressional baby food investigations, FDA "Closer to Zero" initiative, state toxic bans (CA, CT, MN, NJ, NY, WA, VT, WV), Medicaid maternity bundles rewarding prevention. Regulators are demanding solutions.
P2i™ brings a comprehensive three-pillar ecosystem to the market.
1. The P2i™ Doctor Network (recurring revenue + engagement)
• Physicians earn $82,000–$226,000 additional annual income
• Testing margins (40%+) + product resales (10–20%)
• Turnkey AI-enabled workflows (P2i-Insights™)
• Taps existing patient relationships—no new patient acquisition needed
2. The P2i™ CLIA-Certified Testing Lab (Purity Labs)
Lowest cost and most comprehensive body burden testing – mostly reimbursable.
• Proprietary dry blood/urine card technology ($2M+ validated)
• Worldwide shipping with minimal refrigeration or biohazard requirements
• Direct cost advantage over wet sample competitors
• Mass spectrometry-tested for heavy metals, pesticides, endocrine disruptors
3. Consumer Demand
85% of parents concerned about chemical exposures, 60% changed purchasing behavior, 70% willing to pay premium for verified "clean" products. Parents are actively seeking answers.
No player currently delivers the integrated solution: environmental diagnostics + physician network + certified products + outcomes tracking. P2i™ is positioned to own this emergent and transformational product and service category.
3. The P2i™ “Certified Safe” Product Stack P2i™ establishes a post-production testing standard to assure consumers that products are free from potentially toxic chemicals identified as concerning by global experts in the International Federation of Gynecology and Obstetrics (FIGO) 2 . Unified Advantage: The 2i™ Protection Continuum. From hands to surfaces, air, water, and fabrics, the P2i™ “Certified Safe” Product Stack forms a continuously defending ecosystem that merges nanobubble innovation, TiO₂ surface science, and formulations based on FIGO recommendations to safeguard women and children’s health. Scientifically validated, globally scalable, and engineered to elevate wellness in every environment.
Protecting children starts before they’re born.” “
1 https://www.epa.gov/sites/default/files/2017-10/documents/niehs_epa_childrens_centers_impact_report_2017_0.pdf
2 https://www.figo.org/resources/figo-statements/toxic-chemicals-and-environmental-contaminants-prenatal-vitamins
The Stage 1 product suite includes the major things that mothers and families need to reduce the risks of environmental exposure:
Clinically balanced, toxic-screened supplements enhanced with nanobubble solubilization for faster absorption and measurable wellness outcomes.
Mass-Spec Verified + Nanobubble Enhanced – Oregon-made and mass-spectrometry verified to ensure it meets the FIGO standard. Infused with nanobubble oxygenation for superior nutrient stability, taste, and absorption — redefining purity in early nutrition.
HOCl Tablets + Simix + Dr. Shield™ - Medical-grade HOCl tablets deliver hospital-level disinfection at a fraction of traditional cost, eliminating biofilm, pathogens, and allergens. Simix ceramic cleaner-degreaser enhances this system by forming a durable TiO₂ surface barrier that improves reflectivity and resists buildup. When paired with Dr. Shield™ nanocoating, surfaces remain non-leaching and persistently defending, extending protection between cleanings.
Hospital-proven microfiber removes 99.9 % of microbes without chemicals. A core part of the P2i™ ecosystem — clean, rinse, then shield — ensuring safer, sustainable environments.
Nanobubble Skin & Hair Formulations – Advanced nanobubble-enhanced cosmetics and hair care lines deliver deep penetration, hydration, and nutrient delivery without irritation. Clinically clean, stable, and performanceproven for skin and scalp vitality. Products are tested post-production to assure they meet the FIGO standard for environmental toxicants.
6–8 Hour Defense – Alcohol-free, aloe-based sanitizer forming a soft, persistent protective layer on the skin for up to eight hours. Non-drying, non-toxic, and designed to complement P2i’s broader protection suite — for hands, surfaces, and fabrics.
MERV 13A + Dr. Shield™ Option – High-efficiency filters combining superior particulate and VOC capture with negligible pressure drop, eliminating the need for separate carbon filters. When optionally treated with Dr. Shield™, the filter media gains a non-leaching, persistently defending coating that helps inhibit microbial attachment and mold formation — preventing re-aerosolization and extending filter life.
Dr. Shield™ Enhanced Defense – Like air filters, water-filtration systems can accumulate biofilm and mold when not cleaned regularly. Applying Dr. Shield™ coating to filter media creates a non-leaching, persistently defending surface that helps reduce microbial buildup and maintain cleaner water flow between service cycles. This added layer offers an important safeguard against biofilm growth and odor formation in long-use filters.
PFAS-Free + Built-In Antimicrobial Shield – PFAS-free garments with a built-in, non-leaching antimicrobial layer providing persistent protection through dozens of washes. Safe, soft, and naturally defending.
New product line opportunities – P2i™ -developed and third-party “certified safe” – are countless and avail many spinoff and other future value creation pathways for the Company.
P2i™ generates revenue from certified safe products and testing kits. Via Doctor Network-led referrals, it effectively redirects the known existing budget for average families to verified-safe and superior products. It is a substitution model insofar as it does not pursue new spending but instead pursues the substitution of existing spending.
Expectant and new parents already spend an average of $451/month on baby food and clothes, personal care products, supplements, home cleaning, and air filtration.
• No consumer behavior change required — just smarter purchasing in favor of “P2i™ certified safe” products.
• Body burden testing costs are offset by cost savings on products.
Key Financial Model Assumptions
The financial model begins with 10 doctors in the US becoming active as of Month 4, with 10 additional US
Financial Projections
P2i™ provides a rapid path-to-profitability.
doctors added each subsequent month. Total patient engagement and unit volumes compound by 12% per quarter. The international doctor network launches in Month 9 with the same assumption set: 10 initial doctors, expanding by 10 additional doctors per month thereafter, and the same 12% quarterly compounding assumption.
• 40 active patients per physician monthly (c.5% of typical patient count)
• No lifetime value modeling (conservative)
• $451 monthly household aggregate spend (substitution model)
• 12% compounded quarterly growth
• Product margins: 25–65% across categories
These assumptions reflect an intentionally steady and defensible scale-up pace, supporting operational readiness and maintaining the model’s conservative discipline. Milestone
Operational Setup
Revenue Launch
Full Product Portfolio
Cash-Flow Positive
Series A Ready
Months 1–3
Month 4
Month 6
Month 13
Months 18–24
Five-Year Revenue Targets
Year 1
Year 3
Year 5
Launch phase
125 million
$400–650M
Physician training, Shopify integration, 3PL partnerships
10 physicians, $50–100K monthly revenue
30+ physicians, $350–450K monthly revenue
150–200 physicians, $2M+ monthly
400+ physicians, $5M+ monthly, EBITDA positive
40–65% by category
45–50% blended 45–50%
Testing validation
Database outcomes validation begins
Database outcomes validation begins.
$75–150M in database licensing
Supplements
$112.83M
$59.07M
$52.03M
$23.59M
$21.89M
$650.78M
**Plus prospective P2i™ database licensing: est. $75–150M (additional)
Use of Proceeds and Ramp Structure
The $3M convertible note funds P2i™ through full operational launch and cash-flow breakeven by Month 13. Only approximately $1.2M is projected to be deployed in the first 12 months; the remaining ~ $1.8M is maintained as a separate reserve for working capital and scaleup. Spending is concentrated in marketing/physician acquisition and product development, with R&D integrated directly into product builds at manufacturing partners.
The P2i™ medical leadership brings unmatched scientific and medical community credibility and connectivity…
Dr. Jeanne Conry:
MD PhD – Former President of FIGO (global) and ACOG (57,000+ U.S. OB-GYNs).
Dr. Nate DeNicola
MD, MSHP – FIGO Chair of Environmental Health; ACOG Environmental Expert.
Dr. José Cordero
MD, MPH – Former U.S. Assistant Surgeon General; Co-Director, NIH-funded PROTECT study.
Dr. David Berger: MD – A board-certified pediatrician with 25 years of experience in integrative medicine.
(First $1.2M deployed)
• 45% – Marketing & Physician Acquisition
• 20% – Product Development & R&D with manufacturers
• 28% – Operations and implementation
• 7% – Technology & Infrastructure
*No contingency line; reserve is outside this deployment plan
The P2i™ operating team brings strong execution capability…
David Humphrey
JD (CEO) – Founder of Autism Treatment Network (ATN); former CEO of NASDAQ-listed company; 25+ years physician network development.
Bill O'Connor (COO) 40+ years of healthcare/manufacturing operations experience; serial entrepreneur with successful exits.
David Hoffman
(Planning, Program Management & Risk) Former PwC strategy and operations partner; 35 years of international business development experience.
P2i™ is a Category Creator, not a new entrant brand challenger.
Attribute P2i™ Genetic Testing Digital Apps Clean Products Retail Health
Environmental Testing
Physician Network
Certified Products
Longitudinal Database
AI Clinical Support (Six Lines) (RWE)
• Nestlé/Danone: Admits products need testing. Internal and shareholder resistance to cannibalizing legacy brands and retail relationships.
• LabCorp/Quest : Can add toxics testing but lacks physician network credibility and product ecosystem.
• Amazon/CVS: Lack medical society relationships and years of testing including nanobubble validation.
• Regulatory Moat: HIPAA-compliant, CLIA-certified infrastructure supported by global medical-society partnerships (FIGO, ACOG, NIH advisors) provides unmatched clinical credibility and policy alignment.
• Nanobubble Technology Expertise: P2i™ collaborates with advanced nanobubble systems supported by 25+ international patents, applying years of process know-how to deliver superior performance across multiple product lines. This depth of expertise creates a barrier to replication and a clear technical differentiator.
• Data Participation Moat: Participating physicians earn long-term royalty participation in P2i’s aggregated data revenues, aligning incentives without granting data equity or ownership. This structure rewards clinical engagement, sustains loyalty even after retirement, and fuels the continuous expansion of high-quality longitudinal data.
• Economic Moat: Physicians earn $82K–$226K in annual incremental income from testing and product revenue streams, creating high switching costs and deep network retention.
• Network Effects: More physicians richer data better outcomes stronger adoption. The system compounds in value, making replication increasingly difficult
Physician Adoption slower than expected
Patient Engagement lower than expected
Unexpected Regulatory Changes
Large Competitor Entry
Supply Chain disruption
Execution Complexity
Exit Strategy & Return Potential
ACOG/FIGO leadership and medical society access; compelling economics; turnkey clinician workflows
Dr. Berger's network and lived experience validates engagement model and proves substitution economics concept
CLIA compliance from launch, conservative claims based on published research
Physician network + database + proprietary testing create defensible moats
Multi-year manufacturer relationships, backup suppliers, 3PL redundancy
Carefully phased rollout; significant advanced preparation and planning; ready products first; proven team, systems in place
P2i™ offers three high potential exit pathways.
1. Strategic Acquisition (Most Likely, Years 3–5)
Diagnostic leaders (LabCorp, Quest) + Baby food companies (Nestlé, Danone) + Retail health (Amazon, CVS)
Valuation: 5–8x revenue multiples = $2–5B at $400–650M Year 5 revenue
2. Database Licensing (Ongoing)
Longitudinal data asset valued at $500M–$2B
Annual licensing revenue by Year 5: $75–150M
Royalties from government, insurers, pharma, academia
3. IPO/SPAC (Alternative)
Platform companies trade at 5–8x revenue
Potential valuation: $2–5B
P2i™ offers the potential for exception investor returns.
Base Case : $3M investment 15–60x return = $45–180M exit value (after dilution)
Upside Case: 130–270x return = $400–800M+ exit value
Downside Protection: Multiple revenue streams + conservative model + experienced team
With QSBS tax benefits: After-tax returns increase 30–40%
Priority markets: Philippines, Taiwan, Vietnam, Indonesia, India, Mexico, China. Year 5 target: 20–30% of revenue from international ($80–195M).
P2i™ - International Advantages:
• Existing international medical society relationships via P2i™ leadership team
• Premium pricing opportunities
• Efficient IC-DISC tax structure (export tax reduction to 23.8%)
• Robust and engaged Prenatal supplement industry in India
For investors P2i™ represents a top-tier opportunity to enter a categorydefining platform at a historic inflection point, with downside protection through conservative assumptions and upside through multiple exit pathways. Why Invest in P2i™
P2i™ Group Inc. – Portland, Oregon
David Humphrey, JD – Chief Executive Officer Dr. Jeanne Conry, MD PhD – President, Science and Medical Affairs
P2i™ bridges the knowledge gap about the impact of environmental exposures on the health of women and children, from preconception to infancy and beyond.
The health of women and children depends on a healthy planet. Our vision is to advance environmental solutions that improve the health and well-being of women, children, families, and communities.
Women deserve respect, access to care and the ability to make decisions for themselves.
We make recommendations based on science, integrity, and an understanding of the role of environmental exposures and health risks.
Education of health care providers and the public is integral to bringing about change, but collaboration with like-minded organizations must take place to change health care and environmental policy.
The Precautionary Principle is a core tenet: When an exposure poses a threat to health, we should err on the side of caution and limit exposure as much as possible.
Interpret and translate research to form the basis of all proposals, whether they invoke policy recommendations, consumer products, or education curricula.
Educate scientists, health providers and the public on the effect of environmental exposures on reproductive health, preconception health, pregnancy and family health.
Advocate for changes in consumer products so that exposures to potentially toxic chemicals are minimized.
Create an effective certification process, based on P2i™ goals, that allows consumers and practitioners to determine which products provide the greatest safety. A post-production standard of testing is critical for assuring consumers that the product meets these goals.
Use technology to impact outcomes: in the realm of education, research, and implementation science, we will use the tools of social media and artificial intelligence to advance knowledge, improve awareness and foster understanding.
P2i will fill the void in education, advocacy and research that bridges awareness about environment and health.
Knowledge is power. Providing individuals with measurements of their bioburden allows them to change behavior, change product selection, and improve their health and that of their families.
P2i™ turns environmental knowledge into healthier lives. Safe from the start.
P2i™ is a doctor-led program that helps protect mothers and children from toxic chemicals from preconception through age five by reducing toxic exposures, improving nutrition, and giving every child the best possible start in life. Our network of certified doctors uses easy, non-invasive tests to measure toxicant levels and then guides families toward cleaner products and healthier lifestyle choices based on real science. The goal is to prevent health problems before they start—helping children grow stronger, smarter, and healthier. As the program grows, P2i™ is building a unique global database of Real-World Evidence in maternal and early childhood preventive care that links cleaner living to better outcomes and, in parallel, creates long-term value for stakeholders through testing, certified products, and health partnerships worldwide.
P2i™ reimagines the first 2000 days of life — from preconception through early childhood — when the foundations of cognition, immunity, and lifelong health are formed. Through precision diagnostics, certified clean and safe products, and doctor-driven delivery models, P2i™ transforms:
Science into Protection for mothers and children. Commerce into Care by tying maternal purchases to measurable health benefits.
Backed by robust infrastructure, regulatory readiness, and a mission-driven leadership team, P2i™ is positioned to deliver both strong financial returns and a generational impact in maternal-child health worldwide.
P2i™ is established at a historic moment where maternalchild health, environmental medicine, and consumerdriven wellness are converging. Three forces —scientific validation, regulatory pressure, and rising consumer demand — are aligning to create a once-in-a-generation opportunity. P2i™ connects these three forces via an integrated offering comprising lab diagnostics, toxic-free consumer products, data-driven clinician coaching, and system-level prevention to reduce maternal risks and prevent childhood disease from preconception forward. For investors, P2i™ offers entry into a rapidly forming category with the potential for outsized returns, durable market share, and myriad future expansion opportunities.
Rather than competing within crowded product niches, P2i™ is building an entirely new industry vertical that accrues significant and concrete first-mover advantages.
Congressional investigations, state bans, and Medicaid reforms create demand for compliant, preventive solutions – exactly what P2i™ delivers.
Parents and future parents are actively seeking trusted, toxic-free, clinically-backed solutions and are willing to pay a premium.
The combination of lab diagnostics, certified products, and a robust and engaged Doctor Network enables recurring revenue and defensible market leadership.
A revolution in public health is beginning.
For the first time, government, science, and the public are uniting around a simple truth: the explosion of chronic disease in children and adverse health outcomes for women are driven substantively by exposure to environmental toxics 3, poor nutrition, and limited access to care– and much of it is preventable. Awareness is spreading, investment is mobilizing, and stakeholders and markets are seeking solutions capable of addressing this crisis.
P2i™ is uniquely positioned to capture the opportunity availed by this revolution.
By transforming validated NIH science, government and university research of the last decade into a physicianled prevention system, P2i™ protects the next generation while creating a category-defining business model encompassing robust testing, certified clean products, and doctor led, AI-supported preventative care. This is not a future trend – it is happening now. P2i™ is positioned to lead this public health transformation.
P2i™ transforms prevention into action — turning science into protection for mothers and children, and leading a revolution in public health through cleaner living, smarter care, and measurable impact.” “
P2i™ provides a transformational solution for women and child health.
Imagine a pregnancy supported by science and prevention rather than chance. Guided directly by their physician, women undergo P2i™ preconception and prenatal noninvasive biomarker testing to uncover and moderate toxic burdens. They receive prenatal supplements that meet the International Federation of Gynecology and Obstetrics (FIGO) standard that reduces environmental toxicants, live in environments designed to reduce exposures to harmful chemicals, and choose baby food tested to minimize toxics and maximize nutrition. This vision is not the future. It is P2i™ in action today: a platform that translates cutting-edge science into scalable, practical solutions for families.
The Environmental Crisis is Real.
Pregnancy outcomes in America remain unacceptably poor. Rates of miscarriage, preterm birth, and maternal mortality rank among the highest in the developed world. As concerning, more than one in three children now suffer from chronic conditions, including autism, ADHD, asthma, obesity, eczema, and developmental delays. These illnesses not only devastate families but also impose over $600 billion per year in direct and indirect cost on the U.S. economy. P2i™ addresses this crisis via robust, efficient, high-quality, doctor directed, preventive health care, before, during and after pregnancy.
Prevalence of Childhood Diseases
Condition Prevalence Rate
Autism Spectrum Disorder (ASD)
Asthma
Food Allergies
Miscarriage
Preterm Birth
Stillbirth
Celiac Disease
ADHD
Dyspraxia (DCD)
Bipolar Disorder (adolescents)
Childhood Obesity
Childhood Cancer (all types)
Leukemia
1 in 31 (3.2%) children age 8 in 2024
6.5% of children under 18 had asthma in 2024
5.8% of children ages 0-17
10-20% of known pregnancies
10.41% (~1 in 10) of births in 2024
~1 in 175 births
~1% of US population | ~1 in 133
11.3% of children ages 5-17 ever diagnosed
5-6% of school aged children | ~2% severe
2.9% of ages 13-18
19.7% of children ages 2-19
~1 in 285 before age 20
28-33% of all childhood cancers
P2i™ operationalizes longstanding, government supported science into a scalable, physician-led prevention ecosystem…
Science and policy are aligned on the issue of the harms of environmental toxics. Leading U.S. health agencies, including HHS, NIH, NIEHS, CDC, and the EPA recognize that environmental toxicity, poor food quality and access to basic health care are key drivers of chronic disease and overall health. Billions of dollars are being directed toward prevention-focused solutions.
The landmark ECHO and PROTECT studies sponsored by the NIH, which followed more than 60,000 mothers and children over the past decade, demonstrate that reducing exposure to potentially toxic chemicals – specifically endocrine disruptors (commonly found in plastics and plasticizers), pesticides, and heavy metals – leads to improved pregnancy outcomes and neurological health in children. Validated, non-invasive mass spectrometry testing methods adopted by this research are embedded in the P2i™ platform.
P2i™ testing is readily available for clinicians to identify and remedy the toxic exposure of their women and child patients.
P2i™ is a commercial innovation that is, in large part, based upon results from ECHO, PROTECT, University Studies, NIH, NIEHS, CDC, EPA and US Government Superfund Research.
P2i™ turns proven science into prevention for mothers and children." “
U.S. agencies are committing billions towards preventing toxicity-related disease.
Parents are actively seeking evidence-based, non-toxic products and healthcare solutions.Attractive Physician Incentives: Doctors can increase their income by incorporating and implementing P2i™ prevention guidelines.
P2i™ product offerings substitute what families are already spending on unsafe products. Families maintain their existing budget while gaining personalized health insights and a preventative care model for their child’s first four years.
A single child spared from chronic illness delivers a lifetime of economic and well-being benefits.
Reducing toxic exposures can increase conception rates and lower miscarriage risks.
AI-suppconsistent delivery of body-burden test results and personalized prevention programs that overcome legacy barriers in scaling environmental health.
P2i™ addresses the urgent need for effective solutions in environmental health…
P2i™ is entering the market at a historic inflection point in maternal-child health, environmental medicine, and consumer-driven wellness. The convergence of scientific validation, regulatory shifts, and cultural awareness has created a window of opportunity for P2i™ to lead, drive and dominate a newly forming industry vertical we define as:
P2i™ equips physicians with the tools to make prevention practical and scalable. Through lab-based diagnostic testing and clean-labeled certified products, physicians can reduce childhood disease and maternal risks from preconception through early childhood.
P2i™ is a category creator, not just another brand competitor. Rather than competing on individual products, P2i™ delivers a plug-in prevention platform that integrates seamlessly into the workflows of providers, clinics, and families.
By combining non-invasive lab testing, physician certification, consumer products that meet the FIGO standard of safety for pregnancy, and clinician and research-driven data insights, P2i™ enables stakeholders – mothers, doctors, clinicians, and families – to move from reactive disease treatment to proactive disease prevention.
This solution establishes P2i™ as the backbone of a new category in maternal-child health, one that transforms today’s fragmented and unstandardized offerings into a comprehensive, scalable ecosystem – reducing risks, improving outcomes, and creating long-term value for patients, doctors, and payers alike.
Over the last two decades, the CDC, NIH, NIEHS, and HHS have converged around a new understanding: up to 80% of chronic disease risk is, in part, environmentally triggered and not entirely predetermined by genetics. The uterus, placenta, and early microbiome are biological sensors that absorb signals from:
• Endocrine-disrupting chemicals (EDCs) like pesticides.
• Heavy metals like lead, mercury, cadmium and arsenic.
• Phthalates, PFAS, VOCs, and plasticizers.
• Prenatal nutrient levels (e.g., folic acid or folate, omega-3, choline, iron).
• Circadian disruption, hormone imbalance, maternal stress, and small chain fatty acids (SCFA) related to diet.
There has been a surge in published research confirming the link between early toxic exposures and later-life disease risks and neurodevelopmental conditions such as autism and ADHD, asthma, diabetes, obesity, childhood cancers, and autoimmune conditions. Yet, clinical practice has not kept pace with this science. P2i™ closes the intervention gap by transforming molecular-level insights (the bioburden testing) into practical, family-ready care.
Over $350 million in NIH research demonstrates that earlylife prevention is effective. P2i™ effectively operationalizes this breakthrough science.
Today’s parents are digital natives. They don’t trust vague “natural” or “non-toxic” claims — they demand proof. What they want is clear:
Lab Verification – validated results, not marketing fluff. Personalization – tailored solutions, not one-size-fits-all kits.
Clinical-Grade Tools – accessible, at-home, with precision care.
Guidance, Not Guilt – actionable steps from trusted physicians and clinicians, not fear-based messaging. Research from Nielsen, McKinsey Health Institute, and the Environmental Working Group show:
• 85% of new parents express concern over chemical exposures in pregnancy.
• 60% say they have actively changed purchasing behavior because of toxicity concerns.
• 70% are willing to pay more for verified “clean” baby and prenatal products.
• 50%+ say they feel confused or overwhelmed by the current options.
P2i™ meets this demand with science-backed, physicianled solutions that are practical, accessible, scalable, and trustworthy. P2I™ offers clarity, transparency, and control, all in one vertically integrated platform - reducing anxiety and enabling effective decision making and preventative action. P2i™ delivers this science-backed, physician-led plan designed for families who expect rigor, not rhetoric.
The U.S. healthcare and food systems face mounting regulatory pressure to fix maternal-child health failures:
• Toxic Baby Food Reports (2021–2024): Congressional investigations found dangerous levels of arsenic, lead, and cadmium in leading baby food brands.
• U.S. Governmental Accountability Office (2024 ): Assessed the accuracy of over-the-counter prenatal supplements, and almost all had at least one nutrient at unacceptable levels of contamination with harmful substances, such as heavy metals.
• HHS Maternal-Infant Initiative (2023): Federal mandate to address environmental and nutritional risks in maternal-child health.
• Medicaid Maternity Bundles: CMS is shifting to outcome-based maternity care models that reward prevention.
• State Toxics Bans: California, Connecticut, Minnesota, New Jersey, New York, Washington, and Vermont have banned some endocrine disruptors from consumer products. More states are preparing similar laws.
California has now enacted a law that requires prenatal multivitamin manufacturers to test products for heavy metals like arsenic, cadmium, lead, and mercury and publicly disclose the results online.
Our lab testing, clean product design and certification, and traceability systems are built to future-proof compliance and align with current and future government healthcare reforms.
Healthcare delivery is amidst massive change…
• Major players – from Amazon to CVS Health to Walmart and Walgreens – are pivoting toward integrated health platforms.
• Amazon Health now offers full-stack telehealth with prescription and at-home testing.
• CVS Health HUB integrates chronic care with lifestyle services.
• Walmart Health Clinics embed diagnostics, primary care, and pharmacy.
• Kaiser Permanente has launched new mother/infant integration pilots.
P2i™ serves four high-value customer segments. These four segments combine immediate consumer pull (parents), trusted distribution channels (providers), and scalable institutional adoption (public health systems). Together, they create a high-activation, high-retention market pathway with strong recurring revenue potential.
College-educated, middle to upper income, female decision-makers.
Guided by social proof, influencer content, and clinical data.
Premium demand exists for bundled, toxic-free, and physician-verified solutions that protect families and provide peace of mind to mothers and fathers.
Concerned with managing allergies, sleep issues, and developmental issues.
Actively searching for trusted guidance and safe products they can’t find in traditional retail.
Proven clinical results and trusted doctor referrals make P2i™ a powerful engine of organic growth.
OB/GYNs, pediatricians, integrative physicians, family physicians, internists, physician assistants, nurse practitioners, and midwives.
Seeking value-added services that improve patient outcomes while generating passive revenue streams.
Need tools that integrate seamlessly into workflow and meet compliance standards.
Doctor-led trust accelerates adoption and sustains retention.
Public health departments, nonprofits, Medicaid MCOs.
Motivated by outcome-based care and cost reduction in maternal-child health.
Require robust data, equity impact tracking, and turnkey deployment.
Engagements at the public health and Medicaid MCO level deliver nationwide reach and secure long-term recurring contracts.
P2i™ embraces a measurable cycle that structures prevention across six critical windows for mothers and their children.
1. Preconception
(3–12 Months Before Pregnancy)
• Why it matters: The months before conception are critical for reducing toxic body burden and improving health status, preparation for pregnancy.
• What we do: Identify chemical and heavy-metal exposures, reduce risks, address chronic disease and underlying medical conditions, vaccinations and begin the P2i™ prenatal course.
• Impact: Lowers baseline risks for infertility, miscarriage, and developmental disorders.
2. Pregnancy
• Why it matters: Fetal development is sensitive to endocrine disruptors like phthalates, heavy metals, pesticides and PFAS.
• What we do: Track exposures and nutrient status, apply clinical guidance, provide safe supplements, and encourage maternity bundles of care.
• Impact: NIH data links exposure reduction to fewer complications (e.g., preeclampsia, preterm birth).
3. Birth to 12 Months
• Why it matters: Infancy is a window for brain growth and immune development.
• What we do: Use breast milk and baby biomarkers to guide feeding and environment; provide clean formula options, safe sleeping environment including air and surfaces, glass-packed foods, and toxic-free clothing.
• Impact: Supports safer growth, reduced toxic exposure, and stronger immune foundations.
4. 12–24 Months
• Why it matters: Toddler years shape language, learning capability, microbiome stability, and early immunity.
• What we do: Retest for exposures, introduce safe toddler foods and probiotics,
• Impact: Reinforces language learning, resilience, and immune strength.
5. 24–36 Months
• Why it matters: Early childhood is when allergy, asthma, and metabolic risks can manifest.
• What we do: Offer optional biomonitoring and maintain a low-toxicity home and diet.
• Impact: Helps lower risks of eczema, asthma, and metabolic dysfunction.
6. 36–60 Months
• Why it matters: Final stage before school entry - cognition, sleep, and immunity are decisive for readiness.
• What we do: Milestone biomonitoring with nutrition and environmental guidance.
• Impact: Reinforces cognition, immunity, and sleep quality for strong school performance.
Knowledge is Power: Equipping clinicians and patients with knowledge, knowhow and insight is the first step. The testing then enables personalized care, the guiding of precise clinical interventions and sciencebased product recommendations for each family, while enabling adherence-driven retesting across all six critical periods of development outlined above.
P2i™ empowers women to make healthy choices for themselves and their families through testing and guidance by physicians who understand the interaction between the environmental, genetic and social determinants of health.
Delivered via testing, education, and a trusted product ecosystem, P2i™ is designed not just to reduce risks, but to create the conditions for women and children to thrive — physically, cognitively, and emotionally — so they can achieve their full potential.
P2i™ benefits for mothers and children are fivefold:
1. Higher Cognitive Performance
By reducing exposure to toxics linked to neurodevelopmental harm and ensuring optimal nutrition, children have the potential for measurable increases in IQ and cognitive capacity.
The outcome is stronger language development, better memory, and improved school readiness.
2. Safer Pregnancies, Healthier Starts
Lowering maternal exposures to potentially toxic chemicals before and during pregnancy can improve fertility and reduce complications such as preeclampsia, gestational diabetes, and preterm birth.
Healthier pregnancies mean better maternal outcomes and a more stable foundation for lifelong child health.
3. Lower Burden of Chronic Disease
Early reduction of toxic exposures and targeted nutritional support can decrease the risk of childhood asthma,
eczema, metabolic dysfunction, and neurodevelopmental disorders.
The goal is to shift the trajectory from chronic illness management to prevention.
4. Stronger Immunity and Resilience
Healthy nutrition, guided microbiome support, and toxicfree environments build a more resilient immune system.
The goal is fewer infections in early life and greater capacity to adapt to stressors throughout childhood.
5. Emotional and Social Wellbeing
By stabilizing sleep, reducing toxic stress, and supporting balanced neurochemistry, children gain greater emotional resilience.
The goal is confidence, secure attachment, and stronger social skills that carry into adolescence and adulthood.
P2i™ gives every child the best possible start by reducing risk of disease, maximizing the potential for neurodevelopment, resilience, and lifelong health, and unlocking the full human potential.
The P2i™ Business Opportunity is Massive.
P2i™ is the first end-to-end system to operationalize decisive NIH science at scale and deliver it through physicians. With the P2i™ Doctor Network™, prevention becomes part of day-to-day care in clinics worldwide thus transforming the validated NIH research into medical practice. P2i™ creates a scalable model that advances health outcomes while defining a new category in prevention-driven products and medical care that is accessible, practical and profitable.
The P2I™ business model is mission driven with the overriding purpose of improving women and children’s health. It is also commercially viable and attractive, drawing revenue from multiple intersecting industries, each with multi-billion-dollar projections.
Our $1B+ five-year target requires capturing just 0.2% of a $466B U.S. addressable market across five proven revenue streams. With Direct-to-Consumer (DTC) wellness testing growing at 18.86% annually and our doctor network model generating $100-150K per physician, this represents conservative execution in a high-growth sector.
P2i™ delivers unique value to stakeholders by virtue of four key and unique value delivery pillars:
1. A Robust and Motivated Doctor Network
That leads in cost-effectively managing down toxic body burdens in mothers and children, providing safe pre- and post-natal products and services for families, and generating field-leading real-world evidence in environmental health.
2 . An affiliated and captive CLIA-Certified Mass Spectrometry Lab
That leads in accessible, comprehensive, and cost-effective body burden testing for mothers and children, and in testing any and all products to verify non-toxicity and safety.
3.
The P2i™ Certified Product Stack
Appealing and safe essential products for mothers and infants developed, sourced and certified-SAFE by P2i™.
Together, these three pillars form a universal, comprehensive and mutually reenforcing value creation engine for families, doctors and P2i™ stakeholders.
P2i™ is building a robust, engaged and motivated Doctor Network that delivers the P2i™ value proposition to patients, advances the science of environmental health, and profits from doing so.
The starting point into the P2i™ Doctor Network is a vital education curriculum developed by The Forum Institute, a 501(c) (3). Based on this curriculum, P2i™ will certify doctors in the science behind P2i™. These first-of-a-kind courses address environmental toxicity, poor nutrition, body burden testing, and microbiome health—areas of urgent importance where physicians currently lack structured training.
Modeled on NIH/NIEHS research, the certification will show how non-invasive testing and behavior modification improve outcomes in pregnancy and childhood health. The web-based program will be directed by leading experts including Dr. Jeanne Conry, Dr. Nate DeNicola, and Dr. José F. Cordero. The core Master Class (priced under $100) will be supplemented by 10–16 hours of advanced specialty modules, making it accessible while offering deeper training. With a potential audience of more than 500,000 global practitioners —including OB/ GYNs, midwives, nurse practitioners, family physicians, naturopaths, and integrative physicians — the program is expected to achieve broad adoption through medical societies and professional networks.
Developed over the past year, the courses require only modest resources to finalize and launch, and importantly, participating doctors will also be introduced to the P2i™ commercial product portfolio, providing a seamless bridge from education to engagement with the broader program. Expansion of the program is possible by engaging clinicians already aware of environmental determinants of health. Certified clinicians then become active members of the P2i™ Doctor Network.
The P2i™ Doctor Network equips physicians with a structured, science-based approach to preventing pregnancy complications and reducing the risk of chronic disease in children caused by environmental toxics. P2i™ certified physicians also gain access to robust array of tangible commercial benefits including:
• AI-driven database tools that let them review and contribute real-world outcome data on fertility, pregnancy, and childhood disease.
• Non-invasive body-burden and microbiome testing, performed through CLIA and ISO-certified labs, generating high-margin recurring revenue.
• Exclusive P2i™ certified products — including clean prenatal supplements, toxic-free baby food, safe home and clothing lines — available for resale directly to patients, providing easy, automatic, and attractive additional revenues for participating physicians.
• Compliant Management Services Organizations (MSO) support systems that simplify coding, billing and reimbursement processes and minimize revenue leakage.
Over time, the real-world evidence database developed by the P2i™ Doctor Network will create a transformational data asset that supports the advancement of environmental healthcare globally. Participating P2i™ doctors that contribute records will share in the value of this unique asset, in perpetuity. P2i™ provided systems make record keeping and submission quick, efficient, quality-assured, and analytically robust.
Doing Well by Doing Good: P2i™ makes the purpose of improving environmental health for women and children profitable for doctors.
Trained and certified P2i™ clinicians are continuously and comprehensively supported by clinical insights and MSO support services from P2i™. These insights and services are enabled by Docus.AI – a field-proven AI tool and operational support system customized and implemented by P2i™ and branded “P2i-Insights” – that closes the loop between prediction and verified outcomes.
What it does: P2i-Insights™ delivers explainable risk prediction, lab interpretation, and clinical decision support in real time, as well as robust billing and revenue cycle support for that enhance the commercial performance of P2i™ clinicians. The benefits of the Docus.AI knowledge, learning and operational support system are several:
Patient Engagement
Docus.AI provides clear, easy-to-understand explanations of test results so patients know how to interpret and respond to risks.
Accuracy & Trust
Uses medically validated algorithms to reduce ambiguity in lab interpretation.
Efficiency
Helps physicians communicate results quickly and confidently, improving patient compliance and satisfaction.
Allows consistent, standardized risk analysis across large populations, making prevention programs replicable in any clinic or health system.
Translates test results and risk profiles into accurate, compliant billing codes (CPT, ICD-10, HCPCS), reducing claim denials and missed reimbursements. Integrates with EHR and revenue cycle systems to streamline documentation, improve reimbursement speed, and strengthen financial performance across clinical programs.

P2i™ testing is conducted exclusively by Purity Labs – a CLIA certified mass spectrometry lab and an affiliated enterprise of the P2i™.
What it does: Purity Labs serves as a comprehensive, purpose-built state-of-the-art laboratory for P2i™ toxicology, microbiome, and affordable body burden toxicity testing.
Old-Standard Testing: CLIA certification ensures results meet the highest regulatory and scientific standards, giving physicians and patients confidence in accuracy.
Comprehensive Coverage: Beyond toxicology, the lab provides microbiome and biomarker insights, offering a 360° view of environmental and nutritional health.
Actionable Data: Results are structured for integration with Docus.AI, turning lab science into real-world treatment guidance, quickly and cost effectively.
Trust and Compliance: Physicians and institutions can rely on legally recognized, compliance-ready data for patient care, insurance reimbursement, and public health reporting.
Comparable tests to P2i’s in the market today, offered on an ad hoc basis, are 2x to 3x or more expensive than P2i’s planned offerings. P2i™ costs will reduce as scale thresholds are met. P2i™ will accrue advantages of both scale and scope with its body burden and "certified safe" testing regimens.
The Testing Regimen
The P2i™ body-burden testing program measures a mother and infant’s actual levels of heavy metals, PFAS, phthalates, and other toxicants during pre-conception, pregnancy, and early childhood, thereby providing precise guidance to doctors to reduce exposures and bring those levels into a low and healthier range.
Over the five-year P2i™ pathway period, total patient testing costs are estimated to be in the $4,000–$5,000 range and comprise some 30-35 tests. We expect a significant portion of this cost to be covered by insurance as consistent with national precedents.
The tests we perform are the same mass-spectrometry panels used in the government’s ECHO and PROTECT programs, initiatives backed by more than $350 million in federal government investment that have demonstrated meaningful reductions in pregnancy complications and neurodevelopmental disorders when toxicant levels are measured and exposures are lowered. All P2i™ tests are performed on advanced mass-spectrometry systems developed through The Forum Institute and assigned to the P2i™ group.
Every P2i™ test becomes an actionable plan. Parents receive personalized coaching, while OB-GYNs and pediatricians get real-time dashboards, clinical nudges, and cohort analytics. Physicians move from reactive to proactive care with standardized programs.
Together, Docus.AI and Purity Labs integrate real-time, AIdriven insights with gold-standard confirmatory testing. This dual-track approach delivers patients personalized, explainable, and actionable guidance, while equipping physicians with tools that are accurate, efficient, and compliant.
The dual-track approach connects to produce a continuous improvement flywheel of knowledge and knowhow:
Knowledge Building
Clinical Insights
Observed Outcomes
Resting & Verification
Human Confirmation Testing & Prediction
Physician Guided Planning
In concert with the diagnostic, clinical, and MSO-support anchors described above, P2i™ certifies and markets a high-trust product stack that profit a fast path-to-profitability for the Company and immediate, tangible commercial benefits for participating doctors.
Our belief is that any product safe enough for pregnancy is safe for everyone.
In Year 1, P2i™ will bring to market a rich and multifaceted product stack that addresses all of the major touchpoints for reducing exposures to harmful environmental toxicants.
Prenatal & Family Nutraceuticals
Clinically balanced supplements tested post-production for toxic chemicals per FIGO guidelines.
Baby Food — Mass-Spec Verified + Nanobubble Enhanced
Oregon-made and mass-spectrometry-verified to ensure the products meet the FIGO standard.
Home & Surface Care — HOCl Tablets
+ Simix + Dr. Shield™
Medical-grade HOCl tablets deliver hospital-level disinfection at a fraction of traditional cost, eliminating biofilm, pathogens, and allergens. Simix ceramic cleanerdegreaser enhances this system by forming a durable TiO₂ surface barrier that improves reflectivity and resists buildup. When paired with Dr. Shield™ nanocoating, surfaces remain non-leaching and persistently defending, extending protection between cleanings.
Hospital-proven microfiber removes 99.9 % of microbes without chemicals. A core part of the P2i™ ecosystem — clean, rinse, then shield — ensuring safer, sustainable environments.
Personal care products undergo post-production testing to assure they meet the FIGO standard for toxic chemicals. Advanced nanobubble-enhanced cosmetics and hair care lines deliver deep penetration, hydration, and nutrient delivery without irritation. Clinically clean, stable, and performance-proven for skin and scalp vitality.
Alcohol-free, aloe-based sanitizer forming a soft, persistent protective layer on the skin for up to eight hours. Non-drying, non-toxic, and designed to complement P2i’s broader protection suite — for hands, surfaces, and fabrics.
High-efficiency filters combining superior particulate and VOC capture with negligible pressure drop, eliminating the need for separate carbon filters. When optionally treated with Dr. Shield™, the filter media gains a nonleaching, persistently defending coating that helps inhibit microbial attachment and mold formation — preventing re-aerosolization and extending filter life.
Like air filters, water-filtration systems can accumulate biofilm and mold when not cleaned regularly. Applying Dr. Shield™ coating to filter media creates a non-leaching, persistently defending surface that helps reduce microbial buildup and maintain cleaner water flow between service cycles. This added layer offers an important safeguard against biofilm growth and odor formation in long-use filters.
PFAS-free garments with a built-in, non-leaching antimicrobial layer providing persistent protection through dozens of washes. Safe, soft, and naturally defending.
From hands to surfaces, air, water, and fabrics, the P2i™ Safe Product Stack forms a continuously defending ecosystem that merges nanobubble innovation, TiO₂ surface science, and toxic-free formulation. Scientifically validated, globally scalable, and engineered
P2i™ “Certified Safe”
De Minimis Toxicant Testing Standards set limits well below Prop 65, FDA, and European thresholds. These define our internal benchmark for ultra-low toxicant exposure.
Testing results are publicly posted on the P2i™ website for full transparency and easy verification. This stands in sharp contrast to other programs—such as Clean Label—where, it’s impossible to view the actual test results, no standards (many times "pay to play") and where testing is often infrequent and self-reported (sometimes just once a year) with minimal testing (e.g., only four metals and no toxicants). It is imperative for transparency that products undergo post-production testing to assure consumers that the products give new and true meaning a term like “Clean Label.”
By comparison, P2i™ testing covers 24 metals and 120 toxicants, with 16 more analytes planned, ensuring unmatched scientific rigor and transparency.
Moreover, P2i™ certified safe products are continually and systematically batch-tested to ensure that product production runs adhere to the P2i™ Certified Safe standard.
This product stack will be continually expanded into other product categories and include certified third-party brands. Marketing will begin in the US but quickly expand into international markets. As discussed in Section 12, “Post-Launch Development and Expansion Roadmap”, the post-launch business expansion opportunities for P2i™ are many.
Long-Term Value Creation: As families progress through the program, P2i™ builds a governed, de-identified longitudinal database linking exposures, lab-work, interventions, and realworld evidence-based outcomes. At scale, the P2i™ database becomes a high-margin, potential billion-dollar asset for population health, academic research, payer quality programs, and certification analytics. The combination of physician leadership, verified lab data, and auditable outcomes creates a unique and highly sustainable competitive advantage in the environmental health field and in the consumer marketplace.
The P2i™ Doctor Network Buildout is the cornerstone of P2i Group’s global preventive health strategy. By combining the validated Docus. AI engine, fully funded physician onboarding, compliant governance, and scalable Shopify integration, P2i™ creates a network where doctors profit by delivering better outcomes.
Every test, note, and sale strengthens the network’s collective intelligence and economic resilience. P2i transforms individual practices into data-driven, financially empowered nodes of a global health system—setting a new benchmark for preventive medicine worldwide.
Mission
The mission of the P2i™ Doctor Network is to empower every P2i™ certified practitioner with validated tools, integrated systems, and sustainable partnerships that make prevention profitable, measurable, and practical— without administrative or financial barriers.
The P2i™ Doctor Network serves as the operational core of the P2i™ ecosystem, uniting physicians, wellness professionals, and innovators through a data-powered, AI-enabled, and product-integrated ecosystem. The operating model aligns prevention with profitability — empowering practitioners to deliver better outcomes while improving the financial performance of their practices.
P2i™ transforms how healthcare is practiced and rewarded by combining diagnostics, AI, MSO operational support, eCommerce, and outcomes tracking into one physician-led ecosystem. The P2i™ Doctor Network allows clinicians to own their data, their outcomes, and their share of P2i™ enterprise value creation through seamless integration of AI technology, testing, and retail distribution.
The P2i™ ecosystem is powered by four synergistic pillars that build both clinical excellence and recurring revenue:
1. P2i Insights™ – The white-labeled Docus.AI engine customized for P2i, providing AI-driven documentation, charting, and decision support. It automates medical summaries, improves coding accuracy, and enhances patient comprehension through plain-language lab reports.
2. P2i™ Marketing Suite – A fully managed, turnkey digital platform that builds visibility, drives patient acquisition, and integrates with each physician’s eCommerce portal.
3. P2i™ Product & Testing Resale (Shopify Integration)
– Every P2i physician receives a Shopify-powered storefront for selling home test kits, supplements, and certified clean-living products. Margins average 10–20 percent for all physician resales, including testing, devices, and consumable wellness products, creating new revenue without overhead.
4. P2i™ Data Registry (P2i-Insights™ Outcomes) –A longitudinal, anonymized database linking clinical interventions, product usage, and patient outcomes. This system drives predictive analytics and creates a long-term annuity stream for participating doctors.
The P2i™ doctor adoption program comprises a structured rollout that ensures fast, frictionless onboarding across the physician network. P2i™ fully funds every P2i-Insights™ license — typically valued at $100–200 dollars per month — thus removing all financial barriers to doctor participation.
Implementation Procedure
• Orientation (Week 1)
Physician accounts activated with a funded P2i-Insights™ system’s license; EHR connections a configured and branding setup within 48 hours.
• Workflow Integration (Weeks 2–3)
Enable ambient scribe, lab-interpretation, and patientengagement modules. Provide a one-hour webinar and micro-training series.
• Optimization (Month 1)
Track time saved, accuracy metrics, and patient comprehension improvements. Gather clinician feedback for program refinement.
• Quarterly QA Cycle
Aggregate metrics, peer review 10 percent of AI notes, and implement updates network-wide.
This process guarantees uniform deployment, high adoption rates, and continuous improvement across the P2i™ Doctor Network.
P2i™ delivers a tangible value addition for its participating doctors…
1. Documentation Efficiency (AI Scribe)
Ambient transcription reduces charting time by up to 40 percent, freeing physicians for patient care. Structured EHR-ready notes ensure accuracy and compliance.
2. Decision Support and Precision Care
Guideline-based prompts surface risks across environmental, nutritional, and historical factors, improving diagnostic precision and early intervention.
3. Patient Engagement and Education
Converts lab results into plain-language summaries; comprehension improves by over 50 percent, strengthening adherence and trust.
4. Revenue Integrity
AI-enhanced documentation ensures complete, compliant records supporting proper reimbursement.
5. Staff Well-Being
Reduced administrative workload mitigates burnout while enhancing care quality.
P2i-Insights™ employs a multi-layered safety architecture encompassing quality-assured data input, trusted knowledge retrieval, reasoning, and QA scoring. Core medical data sources include NIH, FDA, WHO, PubMed, and ClinicalTrials.gov. The system’s selective memory stores only relevant insights, ensuring HIPAA, GDPR, and SOC 2 compliance, with no external data sales or model training. Continuous expert testing keeps AI outputs clinically aligned.
Each physician’s Shopify storefront represents a fully managed retail channel, allowing seamless integration of diagnostic testing and wellness products into clinical practice.
Key Features
• Inventory, fulfillment, and customer service managed by P2i logistics.
• Doctors earn 10–20 percent margins on all resold testing, devices, and wellness products.
• Real-time sales tracking, automated payouts, and branded packaging for patient trust.
• AI integration aligns store offerings with each patient’s clinical profile for personalized recommendations.
• This model transforms clinical credibility into commercial sustainability, empowering physicians to generate recurring revenue without administrative burden.
Two validated applications of Docus.AI underpin the P2i strategy
1. Purity Labs Implementation
Internal automation for laboratory QA and test interpretation.
2. P2i-Insights™ white-label integration
Physician-facing platform for charting, communication, and preventive analytics.
This dual structure maintains governance separation while leveraging shared validation and compliance. Both use the same vetted Docus. AI foundation for consistency and safety.
The P2i Doctor Network drives growth through four interlinked value channels:
1. Clinical Optimization
AI-driven efficiencies and coding accuracy improve immediate cash flow.
2. Practice Growth
National marketing campaigns expand visibility and new patient volume.
3. Product and Testing Resale
Shopify-based margins (15–20 percent) build passive revenue streams.
4. Data Royalties
Each physician contributes de-identified outcomes data to the registry, earning long-term participation income.
This integrated model enhances both near-term profitability and long-term equity for every participating clinician.
Background
About five years ago, during the development of the P2i™ testing program and related ISO water projects, it became clear that testing had to be delivered for under $200 per test to be viable. Working with a university designated as a Center of Excellence for a leading mass spectrometer manufacturer, Purity Laboratories contributed to key breakthroughs that were later recognized as Project of the Year and became the foundation for CDC and NIH testing programs through institutions such as Mount Sinai hospital and school of medicine.
To complete this work, the Forum Institute contracted Purity Laboratories to perform all development and validation. Purity initially granted the Forum a 2.5% royalty on future test revenue with no cost to Forum. This has now been increased to a 4.5% royalty, accompanied by a structured profit-sharing model with P2i™ Inc.
The program’s major innovation—converting certain tests from wet to dry blood and urine formats—allows samples to be shipped worldwide via standard carriers at very low cost, without biohazard restrictions or refrigeration. This makes international expansion feasible without the need to establish multiple laboratories and ensures long-term exclusivity through proprietary validation and certification.
The following provides a concise overview of the P2i™ testing program. The timeline presented is intentionally conservative—our internal projections indicate completion ahead of schedule. CLIA validation and dry card verification require methodical execution to ensure regulatory compliance and precision.
Core Startup Panel
[Market-ready within 3 months after funding.]
• Heavy Metals
Analysis of 24 toxic elements—including lead, arsenic, mercury, and cadmium—associated with birth defects, preterm labor, and developmental delays. Testing is conducted on dry urine cards and validated for five heavy metals on dry blood spot analysis.
• Microbiome & SCFA Testing
Measures short-chain fatty acids to support immune health, nutrient absorption, and reduction of pregnancy and childhood complications.
• Stress & Sleep Hormones
Evaluates cortisol and melatonin to identify risks associated with preterm birth, gestational hypertension, and impaired fetal development.
• Vitamin D
Detects deficiencies linked to gestational diabetes, preeclampsia, and preterm birth.
• Water Safety (ISO-Certified)
Screens both municipal and well water for heavy metals, industrial contaminants, and bacteria affecting maternal and fetal health.
• Sex Hormones
Detects endocrine imbalances contributing to thyroid dysfunction, infertility, and gestational complications.
• Genetic Panels
MTHFR Folate Metabolism
Identifies variants linked to neural tube defects.
Nutritional Deficiency Panel
Screens for essential nutrients including B12, vitamin D, iron, folate, and omega-3 fatty acids.
Additional Follow-On Panels
• Organophosphates – two-month lag
• Microbiome Expansion – three-month lag
• Phthalates – three-month lag
• PFAS (Forever Chemicals) – four-to-six-month lag
Key Innovation: Dry Sample Technology
Conventional research programs such as the NIH’s ECHO and PROTECT studies rely on wet blood and urine samples requiring refrigeration, biohazard handling, and overnight shipping. P2i™ has developed an innovative dry blood and dry urine system, authorized under CLIA through bridge validation studies demonstrating equivalence to wet methodologies.
This advancement provides major operational advantages
• No refrigeration or cold-chain requirements.
• Low-cost FedEx-compatible global shipping.
• Extended sample shelf life and stability.
• Dramatic reduction in per-sample logistics costs. The dry format applies to heavy metal and hormone testing. Organophosphate and phthalate panels will continue to utilize wet urine methods pending stabilization validation.
Upon completion, the proprietary dry sample platform— particularly for heavy metals and hormone testing— will represent a unique and defensible technology that creates long-term exclusivity and enables large-scale deployment across both public and private health systems worldwide.
For P2i™ products and P2i™ certified safe third-party products, P2i’s Purity Labs tests every single production lot, not just samples.
P2i™ Testing Advantages are many
• Uses de minimis thresholds — the lowest measurable limits for metals and toxicants.
• Tests more than 140 contaminants (including 24 metals and ~120 FIGO toxicants).
• Includes microbiology, allergens, and nutrient adequacy for baby foods.
• Publishes results online, so consumers and physicians can see exactly what’s in each lot.
• Overseen by an independent nonprofit, The Forum Institute, not by manufacturers.
It is the first standard built for maternal-child protection, combining scientific rigor, transparency, and global medical alignment.
Consumers and clinicians can see each lot’s verified results — something neither Clean Label, USP, or NSF currently provide.
[A voluntary manufacturers association. Awards are given to the top third of products tested (meaning many still contain measurable toxicants).]
• Not every lot is tested.
• Relies on retail sampling and sometimes on manufacturer data.
• Manufacturers can “cure” problems and resubmit, so results may change over time.
• Does not publish test data, only issues seals or awards.
[A paid service for manufacturers who apply voluntarily.]
• Testing covers only selected samples, not every lot.
• Manufacturers submit documentation and undergo audits; USP does not test all products on the market.
• No public lot-by-lot data available; the mark simply confirms periodic verification.
• Does not meet de-minimis standard
[Formerly the National Sanitation Foundation, began in 1994 as an independent and accredited organization that develops public health standards and certification programs to test and certify products and systems designed to protect the world's food, water, consumer products, and the environment.]
• Offers product and ingredient certifications for supplements
• Certifies products for safety, a crucial regulatory step.
• Does not address specific concerns regarding safety for preconception, pregnancy, and fetal development.
The FIGO standard for prenatal vitamins is that NO level of the listed toxicant can be considered safe, particularly when women have many sources of exposure over any given day. Neither USP nor NSF requires 24 heavy metals, 120 pesticides, or the CMR list required by FIGO. Nor do they meet the zero (de minimus) measurable level necessary for the FIGO standard.
The FIGO list is much more comprehensive than either USP or NSF. It is based on an independent panel of specialists' recommendations, specifically regarding pregnancy and the safety for a fetus. Postproduction testing can be performed at any ISO-certified laboratory, and the results can be released to obtain P2i™ certification, with P2i™ clearly labeled.
Key Feature
Scope of Testing
Exposure Standard
Transparency
Every lot is tested by independent ISO/IEC 17025 labs before release 24 metals + ~120 toxicants from FIGO’s list + microbiology, allergens, and (for baby foods) phytonutrients
De minimis levels — the lowest technically measurable thresholds, aligned with FIGO standard as safe for pregnancy
Heavy metals (As, Cd, Pb, Hg) + some pesticides/ plasticizers; limited scope
U.S. Pharmacopeia (USP) Verified
Heavy metals and selected contaminants only, as defined by USP monographs
Manufacturer Involvement
Full transparency — results published lot-by-lot for consumers and doctors
Independent nonprofit oversight; manufacturers cannot alter or delay results
Benchmark: “top third” of industry still allows measurable contaminants
No public data; awards issued without publishing actual lab values
Manufacturers can resubmit data or “cure” high results
Meets USP contaminant limits, not de minimis
Purpose
Protect maternal-child health by eliminating exposure and ensuring nutrient adequacy
Marketing-oriented purity award; not medical or clinical in scope
No public data; verification mark only
Manufacturer-initiated participation and data submission
General supplement quality assurance; not specific to pregnancy/child health
Consumer Assurance
Highest level of trust every lot, de minimis limits, public data
Moderate limited sampling, no lot-specific data
Moderate voluntary and partial testing
The Bottom Line -- Only P2i™ Certification offers true every-lot, public, de-minimis testing.
P2i™ will market its own line of products sold through clinics and online via the P2i™ website and other platforms. P2i™ will also certify third party brands that meet the FIGO standard.
The P2i™ product portfolio is carefully designed to deliver a unified experience of clinical-grade prevention, verified safety, and convenient access for families, providers, and institutions. Each product is purposefully linked to and integrated with the diagnostics, recommendations, and environmental realities observed during the P2i™ journey.
From formulation to packaging to fulfillment, the P2i™ product portfolio is informed by rigorous testing, evidence-based research, known consumer demand, and public health impact potential. We offer multiple high-growth, high-impact categories that operate both independently and synergistically through bundled subscription and practitioner-guided pathways.
P2i™ will launch with six compelling product lines that offer mothers and families the tested and certified clean and safe solutions they urgently need now…
Market Size: $88bn (globally)
Clean, safe baby food is in urgent demand. P2i™ will be the first brand in the market to be certified as such and continually tested at a batch level to assure cleanliness. 4
• Small-batch, mass spectrometry-tested baby food in plastic-free pouches and starter jars.
• Certified clean-label sourcing, no detectable heavy metals or pesticide residues.
• Farm-direct partnerships and ingredient-level QR transparency.
• Prenatal shakes and meal replacements (choline, DHA, iron, folate-rich).
• Estimated 65% margin on DTC – 40% wholesale.
• Available in clinical bundles and DTC subscriptions.
4 Appendix J – “Baby & Toddler Foods – Establishing a New Standard in Nutritional Purity and Safety” –defines P2i’s sourcing standards, formulation integrity, and packaging protocols, etc.
5 Appendix G – Nanobubble Personal Care Line – provides a full product line description, plan and applicable scientific backing..
Market Size: $22bn (clean personal care sector)
P2i’s clean-label personal care line leverages nanobubble delivery technology for unmatched safety and efficacy in maternal, postpartum, and pediatric care. 5
• Skincare, wash, lotion, and oral products leveraging transdermal nanobubble oxygen.
• Designed to meet EU endocrine-disruption thresholds.
• Formulations free of phthalates, SLS, parabens, and synthetic fragrances.
• Loan-To-Value (LTV): High due to refill ability and monthly skin protocols.
• Strong crossover potential into adult wellness.
Market Size: $13bn (maternal/pediatric supplement sector)
The P2i™ expansion into comprehensive nutraceuticals is grounded in physician-led formulation, rigorous mass spectrometry-based purity testing, and a global growth plan. 6
• Stage-specific prenatal: conception; 1st tri, 2nd tri, 3rd tri; and postpartum.
• Pediatric omega-3, choline, methylated B-complex, trace minerals.
• Integrates with lab results to personalize protocol.
• Subscription ready with 60% gross margin potential.
The expansion of P2I™ supplement portfolio into a full life cycle nutraceutical line is grounded in physician-led formulation, mass spectrometry-based purity testing, and global market alignment.
Market Size: USD 4–6 trillion (wellness + home sector overlap; USD tens of billions in home wellness cleaning niche)
P2i’s environmental wellness technologies extend the company’s mission of proactive protection into the spaces where families live, breathe, and grow. Developed with leading materials scientists, this collection applies clinical-grade antimicrobial and air-quality innovations to create continuous, synergistic defense within the home.
Each product is designed for safe, daily use and works together to reduce exposure to volatile compounds, pathogens, and microbial biofilms that can compromise early-life health. 7
• HOCl-Based Disinfectants: Clinically pure, pregnancy-safe formulas that eliminate pathogens without disrupting infant microbiomes or indoor air quality
• Antimicrobial Laundry and Surface Defense: Wash-in protection and leave-behind sprays that extend cleanliness between uses—creating a protective fabric-to-surface barrier
• Continuous, Layered Protection: A self-reinforcing hygiene system designed to neutralize threats before they spread—redefining “clean” as proactive rather than reactive
• VOC-Capturing Air Purification Filters: Advanced media that trap volatile organic compounds and allergens, preserving respiratory health for mother and child
• Biofilm-Removal and Prevention Agents: Targeted formulas for kitchens, baths, and nurseries that dissolve microbial buildup and prevent regrowth, maintaining invisible safety
6 Appendix F – Advancing Healthy Home Environments Through Integrated Product and Service Solutions – provides full product line description, plan and science.
7 Appendix F1 – “Safe Home Air and Surface Protection” – provides a full overview of the science and cross-protective mechanisms supporting this product category.
Market Size: $10-20bn (safe textiles market)
P2i™ intends to define a new standard for safe infant textiles. Continuous comfort and protection from the skin outward. P2i™ baby apparel combines LENZING™ sustainable fabrics with Shield Technology™ to deliver toxic-free, breathable, and antimicrobial protection—linking clean materials with early-life wellness. 8
• LENZING™ + Shield Technology™ synergy for lasting, chemical-free protection.
• Evidence-linked to child-health outcomes within the P2i™ global data network.
• PFAS- and toxic-free production using low-impact, sustainable methods.
• Soft, breathable comfort ideal for sensitive, developing skin.
Market Size: $213bn (diagnostic testing; mid-2020s baseline)
P2i’s diagnostic panels are provided by Purity Laboratories, a CLIA- and ISO-certified facility recognized as a Center of Excellence by Agilent Technologies. The P2I™ methodology mirrors the NIH-validated protocols from the PROTECT and ECHO studies, including identical analytes, mass spectrometry procedures, and reporting structures. 9
• Home-collected kits: blood spot, saliva, urine, stool.
• Includes tests for environmental toxics: PFAS, phthalates, metals, pesticides, nutrients (vitamin D, B12, folate), hormones, microbiome.
• Lab revenue: 40%+ gross margins.
• Recurring tests at key milestones during preconception, pregnancy and infancy.
Unlike traditional product companies, P2i’s offerings are continuously optimized through real - world clinical data. Every test result, outcome, and physician recommendation feeds back into our product innovation learning loop:
• Product formulation refinement based on real-world efficacy data from outcomes.
• Personalized protocols driven by individual biomarker patterns across cohorts.
• Outcome-prediction models that improve physician decision-making at the point of care.
• Evidence-based recommendations validated by longitudinal results and retest adherence.
8 Appendix K – “Safe Infant Textiles and Global Standards Framework” – provides further details, design concepts, and data supporting this product line. 9 Appendix C – White Paper – Advancing Public Health Through Non-Invasive Toxicity Testing. Purity Laboratories is the designated testing partner for P2i and will serve as the primary laboratory for both clinical and public health deployments.
The global prenatal, maternal, and early-childhood wellness market is experiencing rapid innovation, with billions invested annually across diagnostics, digital health, and certified product categories.
However, no player today – commercial or institutional – delivers a fully diagnostics-driven, physician-led, and impact-tracked platform that bridges clinical protocols, biomarker-driven risk reduction, and a certified product ecosystem for preconception to the first 5 years of life.
Today’s players are siloed, offering genetics-only diagnostics, lifestyle coaching, unstandardized product certification, and limited digital engagement. P2i™ enters a fragmented market where no single player addresses the complete preconception-toyear-5 prevention journey. There is a clear market space within which to build a much-needed and much-demanded ecosystem that provides integrated prevention and verification.
As of now, the important and guiding clinical advice in the field is provided by The American College of Obstetricians and Gynecologists (ACOG), The International Federation of Gynecology and Obstetrics (FIGO) and the American Academy of Pediatrics (AAP). However, it is the integration of advice across health plans that has been a stumbling block.
Companies like Natera, Illumina, and Invitee focus on genetic screening, but not on environmental exposures. They lack comprehensive prevention protocols and product ecosystems.
Scattered integrative practices provide holistic care but lack standardized care protocols, data systems, and scale.
Preventive Healthcare Platforms: Existing platforms focus on adult populations, whereas P2i™ uniquely targets the critical early-life prevention window.
Supposed clean product providers lack physician integration, are not independently or comprehensively verified, and are not validated by continual, postproduction sample-based assessment.
There are some consumer-facing websites like SafetyNest and Clearya that aim, in part, to educate individual consumers about potential toxics in their environment. But there is no dedicated site of the type to be provided by P2i™.
There are several notable fully integrated healthcare systems In the U.S. that bring together hospitals, clinics, physicians, and insurance/financing under one organization. These systems aim to coordinate care, control costs, and improve patient outcomes, but none of them have included environmental exposures with patient care. Veteran’s Affairs is the largest integrated system; Kaiser Permanente (KP) includes the west coast, Colorado, Hawaii , Georgia, and the northeast US; Geisinger in Pennsylvania; Intermountain Health in Utah, Idaho, Nevada, Colorado, Montana, Wyoming, Kansas are prime examples. None of these integrate any environmental risks and exposures with their healthcare regimen, and certainly not in the critical Preconception to Infancy period targeted by P2i™.
• Natera, Illumina, LabCorp, Quest Diagnostics, Eurofins, Roche, Sonic Healthcare: World leaders in non-invasive prenatal testing (NIPT), genetic carrier screening, and newborn metabolic testing. However, their offerings are almost exclusively genetic, lacking (a) preconception and postnatal biomarker testing, (b) physician-led prevention planning, and (c) integration to product or real-world intervention ecosystems.
• Sera Prognostics: Focused on biochemical risk for preterm birth with the PreTRM® test, but does not extend to exposure-based prevention, ongoing family engagement, or product guidance.
• Ovia Health, Flo, Clue, Ava, Nuvo, Kiddo Health: Provide pregnancy/fertility tracking, symptom journaling, remote physiological monitoring, or app-based newborn wellness resources. While offering personalized digital experiences, they do not bridge into physician-driven diagnostics, certified prevention product sets, or closed-loop real-world health outcome tracking.
• Trellis Health, Bonzun, Bloomlife: Emerging startups using AI to aggregate health data for women, often focusing on fertility and pregnancy; some combine wearables and telehealth. None offer full-spectrum, diagnostics-anchored, pre- and postnatal family journey integration.
• ByHeart, Mamamade, Amara, Little Spoon (clean baby foods), Needed, Ritual, Beli (prenatal supplements): These brands position themselves as “clean” or doctor-backed, but (a) lack integration with personalized testing and protocols, (b) do not partner with longitudinal registries, and (c) often have limited or unverified claims, particularly lacking post-production testing.
• Igenomix , Congenica, Millie, Future Family: Offer advanced reproductive genetics and some expert-guided preconception services but are focused on high-touch infertility/IVF markets, not broad-based population wellness or early-life prevention. Category/Player
Natera/Illumina/LabCorp
Sera Prognostics
Ovia/Flo/Kiddo, etc. Clean
Siloed Solutions
All current solutions are fragmented-either digital-first with little clinical grounding, diagnostics-only with narrow tests, or product-centered without clinical and data rigor.
No one combines CLIA body-burden testing, pre- and postnatal risk reduction, closed-loop provider dashboards, verified product ecosystems, and an outcome registry into a seamless family and provider journey.
Competing brands make health claims but rarely back them with real patient biomarker data or deliver ongoing impact reports to families, physicians, and payers. There is no preventive “Gold Standard” for verification, unlike what P2I™ enables.
P2i™ is the first and only platform to:
• Unite body-burden diagnostics, physician-guided protocols, and certified product delivery.
• Integrate environmentally focused, real-time dashboards for both parents and providers, tracking adherence, exposure, outcomes, and product efficacy.
• Create closed-loop, outcome-anchored certification – the “UL” or “Organic” for early family health – with protocols and standards verified at every stage.
The P2i™ competitive advantage is its unique combination of physician-led guidance, a comprehensive, diagnostics-first platform, and certified product offerings. This is a combination of assets, knowledge and know-how that no would-be competitor has assembled and that will accrue significant and unmatchable network effects over time.
P2I™ enters as a category creator, not a brand competitor - offering a plug-in platform for providers, clinics, schools, and families to proactively prevent disease. P2i™ is not another “wellness” app, test provider, or clean product brand but rather it is a platform category creator.
The combination of diagnostics, closed-loop impact measurement, physician network, certified products, and an expanding data asset is not only defensible but set to redefine how early-life health is not just promised, but proven.
The only integrated platform combining environmental diagnostics and wellness for pregnancy and infancy creates a differentiated and defensible new category.
At-home urine and bloodspot cards, backed by CLIA-certified lab fulfillment, enable scalable, compliant entry into global markets.
Testing products are shippable worldwide, enabling rapid international expansion.
A ready-to-launch line of toxic-free consumer products across nutrition, personal care, and home environment ensures multiple revenue streams and short path-to-profitability.
The backing by leading experts in pediatrics, toxicology, and maternal health establishes clinical credibility and partner trust.
Built for scale with HIPAA, ISO, CME, and eCommerce capacity ensures operational readiness and compliance from day on
Ethical referral and reward system
Tied to every sale drives physician engagement, consumer trust, and long-term brand loyalty.
P2i™ operates across multiple regulated domains (CLIA, HIPAA, FDA, DSHEA). While this ensures defensibility, it also requires ongoing investment in compliance, audits, and legal oversight.
New categories such as nanobubble personal care and toxic-free prenatal products require awareness campaigns and consumer trust-building. Early adoption depends on effective education of both consumers and providers.
Integrating diagnostics, product manufacturing, and provider training under one platform creates some operational complexity. Scaling efficiently will require strong systems and disciplined execution.
Because P2i™ is both a platform and product company, it faces higher upfront capital requirements than single-product competitors, particularly in R&D, compliance, and physician network development. This said, P2i is designed to be maximally capital light.
Large brands in food, baby care, or diagnostics (e.g., Nestlé, Amazon Care) could enter the product space with deep capital, brand recognition, and established distribution.
Potential changes in reimbursement models or stricter enforcement of wellness and supplement claims could create barriers to scaling or require costly adjustments.
Disruptions in sourcing, manufacturing, or fulfillment could delay the rollout of proprietary tests and product SKUs, slowing market momentum.
Broader economic factors (e.g., inflation, shifting consumer spending, or healthcare policy shifts) may impact adoption timelines in both consumer and institutional segments.
P2i™ boasts a set of competitive advantages that will only strengthen over time. These advantages create “moats” – i.e. barriers to entry – that would-be competitors will find very difficult to overcome.
HIPAA-compliant, CLIA-certified infrastructure with multi-year clinical validation and secure data architecture.
• Established partnerships with medical societies (FIGO, ACOG) and NIH-affiliated advisors provide trusted channels for clinical adoption and policy alignment.
• First-to-market advantage within an emerging maternal-child regulatory framework increasingly focused on toxic exposure prevention and validated interventions.
• Proprietary algorithms and AI models that link exposure data to clinical outcomes, trained on physician-validated longitudinal datasets.
• Integrated testing-to-product ecosystem: P2i™’s AI analytics connect diagnostic data to actionable interventions across product categories — food, cosmetics, supplements, and home care.
• Nanobubble technology expertise: Through longterm technical partnerships utilizing systems supported by 25+ international patents (SIO, Japan), P2i™ integrates advanced nanobubble processes to enhance detoxification, nutrient absorption, and antimicrobial performance across multiple formulations.
• Years of applied know-how and direct collaboration with industry leaders create significant replication and integration barriers for would-be imitators.
• High interoperability barrier: The fusion of AI analytics, clinical data, and nanobubble-enhanced products forms a closed-loop system that is technically and operationally difficult to reproduce.
• High switching costs for participating physicians and institutions due to integrated revenue streams, workflow alignment, and data participation incentives.
• Increasing returns to scale as the longitudinal dataset grows in both breadth and depth, reinforcing margins and valuation.
• Royalty-based participation for physicians in data-licensing revenue aligns incentives while maintaining centralized ownership and compliance.
• No comparable physician-led environmental exposure database currently exists, giving P2i™ a first-mover advantage in real-world evidence (RWE) tracking.
• Longitudinal data appreciates in value with scale: each new physician expands the dataset, improving prediction accuracy and outcomes validation.
• Reinforcing cycle: more doctors richer data better outcomes higher adoption — compounding both impact and enterprise value.
Research Led…
P2i™ Clinical Research Database
NETWORK EFFECTS
Doctor Supported…
P2i™ Doctor Network
VALUE DELIVERY
Purpose Driven…
Authoritative Knowledge Source
Trusted and formalized relationships with key medical societies and clinician groups
• Domestic
• International
Seamless testing data integration with NIH and CDC standards and existing datasets
• Integration and collaboration with key research organizations and individuals
Trusted relationships with KOLs
• Public health officials
• Scientists
• Clinicians
• Marketers and pundits
Number of P2i™ certified clinicians and Doctor Network participants
• Committed innovation and advocacy community**
• A committed, motivated and incentivized sales channel
Body of knowledge and knowhow in preventive measures
• Public case studies**
• Clinician case studies**
Body of knowledge and knowhow in treatment remedies
• Scientific input**
• Clinician input**
Number of P2i™ certified products**
Truthful, effective and inexpensive
• Public education
• Consumer and patient education and support
• Clinician education and support
Best-in-Class P2i™ AI Treatment Agent (RAG-based)
Continuous innovation, improvement and public health contribution
• Testing
• Preventative measures
• Treatment remedies
• New product development
• Environmental health field
POSSIBLE LONG-TERM LOCK-INS
P2i™ Doctor Network
Broad-based professional endorsement and spokespersonship
Testing patents
Product patents
Lab rollup (testing scale)
Product market leadership (scale advantages)
Clinician cooperatives (overseas)
P2i™ professional accreditation – standard of care
P2i™ industry standard – product safety
Globally recognized generic brand for public health “movement” (P2i™)
P2i’s financial model is grounded in multi-channel revenue, high-margin product integration, recurring diagnostic and supplement sales, and strategic expansion into wholesale and institutional channels.
With P2i™ product sales providing cash flow and the growing P2i™ Doctor Network and associated datasets providing compounding asset value over time, P2i™ offers robust recurring revenue and extraordinary exit potential.
The P2i™ revenue model anticipates conservative growth curves based on direct-to-consumer sales (DTC), provider sales, and test-kit and diagnostic sales at the household, clinic and corporate levels.
The model assumes that current and expecting parents will reallocate a share of current, existing monthly spend budgets into safe, high-efficacy wellness products and testing that delivers measurably positive health and safety outcomes. By embedding diagnostic testing and clean product categories within the same monthly budget, P2i™ achieves stronger outcomes without increasing cost to families.
The core assumption is a $451 monthly household spend for families with infants. Of this, $104 per month is allocated to P2i™ body burden testing (the amortized monthly amount derived from the estimated $5000$6000, insurance-covered, total spend over five years, mother and child) – while approximately $347 is redirected toward higher-efficacy wellness and household categories such as baby food, clothing, skincare, supplements, and environmental protection
products. This substitution model does not increase total family spending; it reallocates existing budgets towards verified safe products.
For financial modeling purposes, revenue generation is conservatively assumed to begin in Month 4 following initial capitalization and operational setup. While some early revenue may occur in practice, excluding it from the base forecast ensures projections remain disciplined and defensible, emphasizing the credibility of P2i’s underlying assumptions.
Each participating U.S. physician is modeled with an average of 40 active, engaged patients, and each international partner averages 30, representing roughly five percent of an 800–900 patient panel. Sales growth compounds at twelve percent per quarter across all major product lines, with pricing and cost structures are held constant by category. Only engagement rates vary by channel.
Importantly, P2i™ revenue is modeled on a monthlyspend per patient, per doctor—not on lifetime value multipliers, for example repeat sales, word-of-mouth sales, or increased family spending.
Influencer, eCommerce, and Retail Channels are modeled proportionally to these figures at 25% of the U.S. doctor baseline (100 units), reflecting scaled consumer reach and engagement relative to physicianguided sales. All channels share a 12% compounded quarterly growth rate. Pricing and COGS remain constant across markets.
Lower/slower physician adoption than expected…
Mitigation: P2i’s leadership includes past ACOG/FIGO presidents. Certification Courses and turnkey workflows reduce implementation hurdles for clinicians
Lower/slower patient engagement than expected…
Mitigation: P2i team experience (Dr. Berger's and others in his network) demonstrates a proven engagement model for families. AI-supported personalization will further improve engagement
Unfavorable regulatory shifts – policy change or policy confusion could slow P2i™ diffusion. Current policy trendlines, however, are positively supportive, globally.
Mitigation: CLIA compliance from launch. Conservative health claims are based on credible, published, scientific research.
Competition Risk … P2i™ enters the market as a category creator and faces no direct competitors or contenders at this time. But competition will undoubtedly arise.
Mitigation: Physician-led approach, Doctor Network, and longitudinal data registry create powerful defensive moats. First-mover advantage in the preconception to the 0-5 age segment provides significant network effects.

Prepared October 8, 2025
Net Sales COGS
Gross Profit
Sales & Mktg. Expenses
Operating Expenses
EBITDA
Amort., Dep., Int., etc.: Taxes
Net Income
Flow
Net Income
Operating Investing Financing
Cash Inc./(Dec.)
Beginning of Period End of Period
Balance Sheet
$9,924,280
$5,235,682
$4,688,598
$2,941,079
$2,068,989 ($321,471)
$0 $0 ($321,471) ($321,471)
$14,477
$0
$3,000,000
$3,014,477
$0
$3,014,477
$71,366,497
$34,494,944
$36,871,553
$16,486,091
$5,513,718
$14,871,745
$0
$4,416,908
$10,454,836
$186,451,754
$88,583,547
$97,868,207
$43,104,449
$11,268,522
$43,495,236
$0
$12,918,085
$30,577,151
$368,180,574
$173,957,203
$194,223,371
$85,145,869
$19,821,108
$89,256,394
$0
$26,509,149
$62,747,245
$654,130,160 $308,298,130
$345,832,030
$151,297,853
$33,095,052 $161,439,175
$0
$47,947,435 $113,491,740
$10,454,836
$11,126,473
$0
$0
$11,126,473
$3,014,477
$14,140,950
$30,577,151
$31,781,000
$0
$0
$31,781,000
$14,140,950
$45,921,950
$62,747,245
$64,641,550
$0
$0
$64,641,550
$45,921,950
$110,563,500
$113,491,740 $116,472,229
$0
$0 $116,472,229 $110,563,500 $227,035,729
Liabilities
Liabilities & Equity
$3,014,477 $0 $3,014,477
$335,947 $0 $335,947
$2,678,529 $3,014,477
$14,140,950 $0 $14,140,950
$1,007,584 $0 $1,007,584
$13,133,366 $14,140,950
$45,921,950 $0 $45,921,950
$2,211,433 $0 $2,211,433
$43,710,517 $45,921,950
$110,563,500 $0 $110,563,500
$4,105 ,738 $0 $4,105,738
$106,457,762 $110,563,500
$227,035,729 $0 $227,035,729
$7,086,227 $0 $7,086,227
$219,949,502 $227,035,729
$250,000,000
$200,000,000
$150,000,000
$100,000,000
$50,000,000
$1,400,000,000
$1,200,000,000
$1,000,000,000
$800,000,000
$600,000,000
$400,000,000
$200,000,000
($200,000,000)
For what it’s doing, P2i™ is a capital light business…
• A $3M convertible note funds provider success systems, marketing and certified product R&D inventory through positive cash flow in Month13.
• A follow-on Series A (in 18-24 months) for network scale, international pilots, and registry commercialization that maintains QSBS eligibility through best-in-class data asset management.
P2i™ is strategically structured for maximum after-tax efficiency. As a U.S. C-corporation with less than $75 million in gross assets, it qualifies for Qualified Small Business Stock (QSBS) status—allowing founders and investors to exclude up to 100% of capital gains (up to $15 million or 10× basis) on shares held for at least 5 years. In many states, this exclusion also extends to state income tax, making potential exits effectively tax-free.
International operations further leverage an IC-DISC structure, reducing the effective tax rate on export income from 37% to 23.8% through qualified dividend treatment.
• Together, these structures create a powerful tax-optimization engine and substantially increasing investors’ after-tax returns
With a significant share of projected sales outside the U.S., P2i™ is ideally positioned to leverage the Interest Charge–Domestic International Sales Corporation (IC-DISC) structure.
• An IC-DISC allows a U.S. company to treat qualifying export revenue (including U.S.-made diagnostic kits, baby food, and supplements sold abroad) as a special dividend taxed at capital gains rates rather than ordinary income rates.
• This can reduce effective tax rates on export profits from ~37% to ~15%, creating a material lift in after-tax earnings.
• The result: Investors benefit from both domestic QSBS tax-free capital gains and international tax efficiency on global revenue streams.

2i's greatest strength is a leadership bench that has already built physician networks, clinical datasets, and multi-faceted commercial ecosystems.
Jeanne Conry, MD PhD – Medical Leadership: Past President, The International Federation of Gynecology and Obstetrics (FIGO) and The American College of Obstetricians and Gynecologists (ACOG). Leads clinical strategy, physician engagement, and medical-society alignment; provides credibility for OB-GYN adoption and international expansion. Twenty-year leadership position in The Permanente Medical Group, Kaiser Permanente, Roseville-Sacramento, California.
Nate DeNicola, MD, MSHP, FACOG – Environmental Health Policy and Capacity Building: Environmental Health Chair, FIGO. Bridges science and policy; guides exposure-risk frameworks, provider education, and international NGOs aligned with public health initiatives.
José F. Cordero, MD MPH – Public Health & Epidemiology: Former U.S. Assistant Surgeon General. Co-Director and Investigator of NIH funded PROTECT which underpins the P2i™ testing. Advises on registry design, outcomes measurement, and population-health partnerships.
David Berger MD, FAAP – Clinical Models & Outcomes: Integrative pediatrician. Provides the operating blueprint for treatment protocols and the family-level adherence model.
David Hoffman – Strategic Planning & Organization Development: An international business development expert, David is a Senior Advisor to The Conference Board and a non-resident fellow at both the Center for Strategic and International Studies and The Rand Corporation. Leads strategic planning and program management.
Lee Grossman MPH – Advocacy & Ecosystem Partnerships: Former CEO, Autism Society of America. Catalyzes payer, employer, and advocacy-group relationships; supports outcomes storytelling and benefits integration.
David Humphrey JD – Preventive Health, Global Collaboration & Scientific Impact-founder, The Forum Foundation. Founder and CEO of Purity Labs. Builds cross-sector alliances to accelerate physician-led data collection and certification uptake.
Bill O’Connor – Operations & Marketing: Health-tech business and product developer and scaling expert. Orchestrates GTM sequencing, provider-success playbooks, and enterprise channels without diluting clinical focus.
*See Annex 1 for Detailed Bios and Professional Capabilities
Board of Directors
CEO
David Humphrey
• Lab Operations
Strategy Officer
David Hoffman
• Strategic Planning
• Program Management
• Risk Management
• Treasury and Internal Control
Medical Director
Dr. Nate DeNicola
• OB-GYN Engagement
• Environmental Health Advocacy
• Clinical Solutions
Lee Grossman – Chairman
• David Humphrey
• David Hoffman
• Dr. Nate DeNicola
• Dr. David Berger
President
Science & Medical Affairs
Dr. Jeanne Conry
• Certification Program
• Medical Society Engagement
• Compliance
COO
Bill O'Connor
Scott Clark Product Development
Robert Williams Business Development
Travis Armstrong Sales
Clinical Models
Dr. David Berger
• Pediatrics Engagement
• Real World Evidence Generation
• Clinical Solutions
Epidemiology
Dr. José F. Cordero
• Clinical Database Construction and Management
• Institutional Engagement
P2i’s operational model is designed for scalability, efficiency, and compliance. Instead of building and managing its own warehousing infrastructure, P2i™ will operate through an integrated logistics network anchored at the Purity Labs facility which serves as the company’s administrative and operational headquarters. Fulfillment and distribution will be executed through a national and international network of third-party logistics (3PL) partners, ensuring rapid delivery, regulatory compliance, and flexible scaling.
The P2i™ fulfillment strategy blends centralized administrative control with distributed operational execution. The Purity Labs facility, located in Portland Oregon, functions as the central hub for coordination, compliance, financial reconciliation, and technology integration. From this command center, product inventory flows to multiple 3PL partners strategically located across the United States and abroad. These partners handle receiving, storage, order processing, and shipment to customers or practitioner partners.
This hybrid structure minimizes fixed costs while providing a highly scalable and responsive logistics system capable of supporting the full suite of P2i™ product lines—ranging from HomeSafe cleaning systems and HOCl - based wellness sprays to nutraceuticals, baby food, and practitioner kits.
P2i’s 3PL network manages core logistics functions including storage, inventory management, order processing, packaging, shipping, and returns. Orders originating from Shopify and other digital storefronts automatically integrate with each fulfillment center’s warehouse management system (WMS). This seamless data flow provides real - time visibility of inventory, order status, and delivery tracking.
Each 3PL partner operates under strict service level agreements (SLAs) requiring 99 percent order accuracy and same - or next - day fulfillment for most shipments. Multiple nodes across the United States—typically East, Central, and West—ensure one - to two - day delivery times nationwide. For international expansion, P2i™ will implement a similar model in Asia (beginning in the Philippines) and later in Europe, using regional 3PL providers and bonded storage facilities to minimize customs friction and delivery delays.
Purity Labs serves as P2i’s operational headquarters, overseeing supply - chain coordination, quality assurance, and administrative management. The facility receives products directly from manufacturers for validation, lot tracking, and distribution allocation. From there, Purity Labs dispatches inventory to U.S. and international 3PL facilities based on real - time demand forecasts.
In addition to its administrative role, Purity Labs maintains compliance oversight for all regulated materials— including disinfectants, wellness sprays, and diagnostic products. The lab’s existing certifications and operational standards provide a strong foundation for managing both domestic and international shipments while ensuring all products meet applicable OSHA, EPA, and export control regulations.
The logistics system is fully integrated through P2i’s digital backbone, connecting Shopify for order management, QuickBooks for accounting, and Zoho Inventory for real - time stock tracking. Carrier APIs (UPS, FedEx, DHL, USPS) automatically select the lowest- cost and fastest shipping option for each order. This technology integration reduces fulfillment errors, enhances operational transparency, and provides unified visibility across all entities in the supply chain.
Scalability
• The 3PL model allows rapid expansion into new product lines or market regions without significant capital expenditure.
Cost Efficiency
• A variable cost structure replaces traditional warehouse rent and labor expenses, allowing resources to scale in proportion to demand.
• Centralized oversight at Purity Labs ensures all fulfillment partners adhere to U.S. and international compliance standards.
• Distributed logistics nodes support rapid delivery across the United States and efficient routing for international markets.
• Financial and inventory systems are synchronized across all facilities, providing real - time monitoring and accurate forecasting.
The P2i logistics framework combines Purity Labs’ centralized administrative leadership with a distributed 3PL fulfillment network to deliver scalability, reliability, and global reach. This operational model enables P2i to efficiently manage complex product lines while minimizing overhead, ensuring consistent quality, and supporting rapid market growth both domestically and internationally. 10
10 Appendix H – “Expanded Operations and Logistics” – P2i’s operational model is designed for scalability, efficiency, and compliance. Instead of building and managing its own warehousing infrastructure, P2i will operate through an integrated logistics network anchored by Purity Labs, which serves as the company’s administrative and operational headquarters.
P2i™ brings a unique approach to the market by integrating diagnostics, preventive wellness, and trusted distribution under one physician-anchored platform. The company’s marketing and sales strategy begins with establishing credibility, specifically building confidence among healthcare providers and aligning early adoption with respected medical channels. From this beachhead, the program expands outward through carefully measured consumer and influencer engagement.
The plan is intentionally conservative in its early phases, emphasizing efficiency, accountability, and measurable return on marketing spend. Each marketing action— whether provider certification, influencer activation, or paid media—is triggered by validated performance data. This ensures that growth occurs only when profitability thresholds and engagement metrics are met.
P2i’s marketing strategy balances provider-first credibility with performance-driven digital channels. We concentrate on the platforms, most likely to deliver measurable ROI and accelerate adoption. The goal is to secure rapid trust among providers, build demand among families, and create scalable referral loops that compound over time.
The P2i™ marketing strategy is built on a comprehensive ecosystem of tools and vendor partnerships that power execution and measurable growth. This appendix provides a detailed view of the marketing technology stack, covering influencer platforms, campaign management systems, analytic solutions, and ROIdriven tactics that create an integrated foundation for scalability and precision outreach.
The marketing system is designed to deliver ROIverified growth by combining provider-first adoption, performance platforms, and disciplined budget allocations.
1. Provider-Led Entry
Physician adoption is the foundation of P2i’s credibility and organic reach. Certified providers act as both trusted advocates and localized distribution points, guiding patients toward diagnostic testing and recommended wellness products. Early campaigns focus on professional awareness, onboarding support, and the Certified Doctor SEAL program, which establishes visible quality assurance at the point of care.
2. Community & Influencer Engagement
Once credibility is established through the provider channel, the brand amplifies through social and educational networks. Using structured influencer programs and measurable affiliate systems, P2i expands its visibility across parenting, wellness, and women’shealth communities. Influencers serve as educators and early adopters rather than pure promoters, linking families directly to certified providers and approved testing bundles.
3. Consumer Education & Conversion
For families, the marketing funnel centers on clarity and trust. Educational content—ranging from blogs and webinars to short testimonial videos—connects diagnostic awareness to actionable wellness steps. Targeted retargeting ads and referral incentives move families from interest to enrollment while maintaining a disciplined cost of acquisition.
• Tagline: Test. Trust. Transform.
• Core Promise: Every mother deserves clarity and peace-of-mind from toxic chemicals; every child deserves a safe start.
• Proof Points: CLIA-certified labs, ISO protocols, and NIH-replicated methodologies underscore scientific integrity.
• Positioning: P2i™ stands as the only integrated environmental ecosystem where trusted medical professionals, verified diagnostics, and clean wellness solutions work in synergy.
• Digital Infrastructure: Unified websites, patient portals, and analytics create a measurable foundation for acquisition and retention.
• Provider Outreach: Select campaigns through medical networks introduce certification and reseller participation.
• Influencer Programs: Micro-influencers launch smallscale campaigns to generate authentic content and awareness before larger budget expansion.
• Content & SEO: Online/website educational materials serve dual roles—organic traffic generation and practitioner education.
• Paid Media: Strictly retargeting in early phases; full acquisition campaigns begin only once profitability is proven.
Every marketing and sales activity operates within a budget-gating framework. Expenditures in paid, influencer, and content channels are released only when key metrics—conversion rate, cost per acquisition, and lifetime value—meet or exceed predefined thresholds. The analytics stack consolidates these data streams into unified dashboards for executive review, ensuring continuous accountability.
The focus on Customer Acquisition Cost (CAC) /LTV efficiency drives long-term financial performance: customer acquisition remains conservative while lifetime value expands through recurring diagnostic testing, product subscriptions, and multi-year family retention. This disciplined methodology transforms marketing from a cost center into a predictable, scalable growth engine.
• Phase 1 (0–6 Months)
Establish Brand Foundation – Website launch, SEO, pilot provider outreach, and early influencer seeding.
• Phase 2 (4–12 Months)
Scale Engagement – Expand influencer programs, certification marketing, and retargeting media.
• Phase 3 (12–24 Months)
National Expansion —Add institutional partnerships, larger paid media campaigns, and advanced analytics optimization.
P2i’s marketing and sales strategy is designed to scale trust before reach—building early adoption through medical credibility, expanding awareness through influencers and digital precision, and sustaining growth through ROI-verified systems. The result is a platform that grows responsibly, guided by data, compliance, and disciplined financial management. 11, 12
11 Appendix B – “Marketing Execution Playbook” (Conservative Rollout Edition) – details tactical plans, compliance frameworks, and performance dashboards supporting this strategy.
12 Appendix A – “Go-to-Market Architecture & Channel Governance” – Provide a clear, concise go-to-market playbook that aligns pricing, channels, logistics, analytics, and governance into one execution-ready guide.
Robust P2i™ planning done over the last two-plus years will enable a rapid go-to-market rollout.
The physician channel, via P2i™ certified training, is the primary market entry point. As that channel ramps, there is significant potential to expand distribution through influencers, eCommerce, direct-to-consumer sales, retail partnerships, and international affiliates. With doctor-led credibility as the anchor, brand recognition could drive $4–$10 in external sales for every $1 sold through the physician channel. These sales would leverage the same certification and testing infrastructure, extending P2i’s reach far beyond the clinic.
The core business will be rolled out as follows:
1. Doctor Certification
1.1 Curriculum & Program Development
1.2 Enrollment
1.3 Certification (US)
1.4 Certification (Int’l)
2. Testing
2.1 Core Panels (heavy metals; microbiome; hormones; stress; sleep; nutrients; genetics)
2.2 Organophosphates
2.3 Microbiome Expansion
2.4 Phthalates
2.5 PFAS
3. Products
3.1 Clinical Testing
3.2 HomeSafe Kits
3.3 Skincare
3.4 Haircare
3.5 Baby Food
3.6 Baby Clothes
3.7 Supplements
4. Doctor Network & MSO Enablement
4.1 Pilot Activations
4.2 Clearinghouse & Billing Integration
4.3 EHR / PM Integration
4.4 Remittance Automation & Analytics
4.5 Advanced Orchestration & RPA
5. Marketing
5.1 Website launch | HIPAA compliance | Baseline content | Doctor outreach
5.2 Influencer onboarding | SEO / Blog ramp | Certification marketing
5.3 Social & UGC campaigns | Doctor certifications | SEO scaling
5.4 Paid retargeting | PR / media activation | Pilot preparation
6. Marketing Channels
6.1 US Doctors
6.2 Influencers
6.3 Ecommerce
6.4 Int’l Doctors
6.5 Retail (US)
Healthcare practices are shifting from isolated billing tools toward fully orchestrated digital ecosystems. Docus.AI will be extended from being P2i’s AIpowered testing, interpretation, and treatment analytics engine into a unified orchestration hub that integrates seamlessly across the clinic’s revenue cycle, EHR, clearinghouse, and payer systems. This ensures interoperability, transparency, and automation throughout the medical claim lifecycle.
Specifically, the Docus.AI platform will be integrated with EHR/PM, clearinghouses, and payer APIs to automate coding, compliance, eligibility/PA, claim generation (837P/837I), and remittance posting (835), with adaptive
Medicaid/MCO rule updates.
Expected gains for participating P2i™ Doctor Network clinics include: ≥95% first-pass yield, 10–25% fewer denials in 90–120 days, 5–10-day DSO reduction, and 20–35% fewer manual touches, all with audit-traceable edits.
Rollout progresses from side-by-side to hybrid overlay to full orchestration. The result is a unified and learning Management Services Organization (MSO) for clinical, financial, and compliance performance that adds significant value for P2i™ Doctor Network clinics and binds doctors tightly to the P2i™ ecosystem.

1.
International expansion will be pursued as soon as initial and foundational US operations are established. Based on P2i™ market research, international markets offer both increased flexibility in Doctor Network business models – e.g. Doctor cooperatives – as well as premium pricing upsides based on the consumer behavior specific to these markets.
Rapid development is expected in international markets based on the existing, seniormost medical society relationships of the P2i™ team. Priority international markets include Taiwan, the Philippines, Mexico, India, Vietnam, Indonesia and China among others.
The business plan presented thus far focuses on six product lines and three core operational pillars to ensure the most expedient path to profitability and first mover advantage. From this foundation, significant business development and expansion opportunities will be layered in and developed to create substantial future upside. Each expansion opportunity outlined below strengthens the defensibility of the P2i™ model, compounds the value of the P2i™ clinical data and learnings, and broadens adoption well beyond the initial physician-led rollout. Planning and groundwork for all these expansion initiatives is already substantively completed. 2.
The initial portfolio focuses on baby food, diagnostics, clean household products, cosmetics, supplements and baby clothing. Over time, adjacent categories - including bedding, cribs, toys, shampoos, and additional family products - will be developed or licensed under the P2i™ certification seal. In addition, third-party licensing will enable companies (e.g., a major baby brand) to produce P2icertified goods under royalty agreements, extending influence and revenues with minimal incremental cost.
• Nanobubble Line Expansion – Nanobubbles will become a standalone innovation pillar for P2i™ product stack. For women’s and maternal health, nanobubble-infused supplements, hydration, probiotics/prebiotics, HOCl sprays/serums, and non-irritant cleaners improve absorption, recovery, skin healing, and hygiene. Cosmetics are a core first offering, with expansion into oxygenated serums, HOCl mists, anti-aging/brightening, clinic-grade concentrates, and postpartum-safe lines. Consumer uses include baby food, functional beverages, nutraceuticals, and home wellness systems. Enterprise uses span facility cleaning and biofilm control, air/water purification, and food-service sanitation. The platform adds high-margin, defensible differentiation across markets.
We expect that, as P2i™ gains in awareness and momentum, other third-party brands will become keenly interested in joining “the movement”, beginning with those brands already positioning in the “safe product” including companies like The Honest Company, Healthy Baby, LEESA (mattresses), Hiya (vitamins), Little Spoon. etc. P2i™ will test and certify these products earning certification fees and benefitting from cobranded promotions. These promotions will extend to appropriate retailers – grocery and super stores – who wish to promote clean and healthy products. P2i™ will monetize these relationships via licensing fees, promotional fees, and other mechanisms. Our ethos is: the more vendors that sell safe and clean, P2i-certified products, the better.
While the near-term focus is on preconception and infancy, the same environmental testing and certified product framework can be extended to a wider base of providers: internists, geriatricians, naturopaths, and integrative physicians serving children through to the elderly. With rising demand for solutions addressing microplastics, PFAS, and chronic toxic exposures across all ages, this broader network could replicate the maternal-child model, expanding the addressable market geometrically without major increases in infrastructure. If a product is safe enough for a pregnant mother, it is safe for everyone.
P2i™ Telehealth will provide patients—especially those without a P2i™-certified doctor—with access to virtual consultations focused on fertility, preconception, pregnancy, and early childhood wellness. The envisaged program will connect users to trusted environmental-health physicians who specialize in reducing toxic exposures, optimizing nutrition, and improving outcomes for mothers and infants.
The P2i™ Doctor Network is a cornerstone of the Preconception to Infancy (P2i™) enterprise, bridging the gap between clinical expertise and consumer trust. This network is composed of physicians, nurse practitioners, midwives, and physician assistants who have completed the P2i™ Certification Program—a rigorous curriculum in environmental toxicology, reproductive health, and early childhood development. Each certified clinician earns the distinction of being a “P2i™-Certified Provider,” recognized for adhering to the highest standards of scientific integrity and patient safety.
P2i™-Certified Providers are uniquely positioned to offer laboratory-based environmental exposure testing and interpretation as part of their clinical practice. By integrating this service into routine preconception, prenatal, and pediatric care, the network empowers patients to identify and mitigate toxic exposures that can impact fertility, pregnancy outcomes, and early child development. These clinicians serve as the clinical front line of P2i™’s mission—to translate advanced toxicity science into actionable healthcare.
The most scalable component of the P2i™ Doctor Network is its envisaged telehealth platform. This ondemand service connects patients nationwide with P2i-Certified Providers for personalized counseling on toxicity, pregnancy, and child health. Patients can receive expert guidance on product safety, environmental exposures, and laboratory results from trusted clinicians trained in the P2i™ standard. The telehealth model provides accessibility, scalability, and continuity—extending P2i™’s reach beyond brick-and-mortar clinics to serve families wherever they are.
By integrating certified clinicians, laboratory testing, and telehealth delivery, the P2i™ Doctor Network transforms a seal of safety into a scalable healthcare movement—anchored in science, delivered by trusted professionals, and positioned for significant growth in the emerging market of preventive and environmental health.
The P2i™ Doctor Network is positioned to build one of the world’s most valuable longitudinal medical datasets that links environmental exposures, pregnancy outcomes, childhood illnesses, and effective interventions.
Such datasets have historically commanded valuations between $1,500 and $15,000 per patient record, depending on depth and usability. With participation scaling from 1,000 to potentially 10,000 physicians, the number of patient records could support a database valuation exceeding $500M to $2B under current market methodologies.
• Revenue Model: Rather than outright sale, the database could be licensed on a recurring basis, generating 7–10% royalty streams from government, insurers, and research users.
• Timing: Licensing revenues may emerge in years three to four as outcomes are validated and adoption scales.
P2i™ will expand from consumer wellness into a corporate health by extending its certified ecosystem (diagnostics, baby food, cosmetics, clean household) into workplaces, institutions, and small businesses. The WIMPER program lets employers offer medically supported testing and certified products under compliant reimbursement, unlocking about $175 per employee per month via reduced FICA, with no payroll change. Patient and provider referrals seed employer demand. Distribution scales through corporate partnerships, insurance/broker networks, public-sector pilots, and international licensing. The model compounds impact—financial, medical, environmental—under one tested, compliant framework.
Roughly half of U.S. employees are covered by self-insured companies that bear direct responsibility for medical costs. Since pregnancy-related costs are the largest expense category, these employers have a vested interest in prevention. Reducing preterm births by even 10% could save corporations tens of millions annually (a preterm birth averages $70,000 vs. $7,000 for a standard delivery). Direct contracting with large employers such as Amazon, Tesla, or GM represents a powerful future sales channel, backed by physician credibility and measurable outcomes.
Medicaid covers 40–45% of U.S. births and is actively piloting value-driven maternity care bundles. Under these models, physicians can share up to 25% of the documented savings when pregnancy complications are reduced. For example, lowering pre-term rates from 10% to 8% generates substantial shared-savings revenue for participating providers. P2i’s prevention protocols and database tracking uniquely position it to thrive in these arrangements, unlocking a new dimension of scalable growth.
The evolving regulatory and socio-political landscape avails an opportunity for a P2i™ Legal Strategy Division to serve as both a litigation catalyst and corporate shield, addressing violations before crises hit and transforming brand liabilities into reputational assets via:
• Expert testimony & consulting.
• Litigation prep packages.
• Corporate retainers ($250K–$5M/year).
• Compliance service fees.
• Nonprofit enforcement collaborations.
P2I™ operates in a highly regulated landscape that includes clinical diagnostics, nutritional supplements, personal care products, and digital health services. Our compliance strategy is embedded from inception, ensuring we meet the highest standards for safety, privacy, and ethical integrity while supporting rapid scalability and multi-jurisdictional expansion.
P2i™ has engineered its platform to meet or exceed U.S. and international standards in diagnostics, product safety, and data privacy. This ensures both regulatory defensibility and scalability across global markets.
P2i’s regulatory-first strategy makes P2i™ not only defensible against litigation and compliance risk but also positioned for international expansion. It builds trust with doctors, institutions, and regulators, ensuring market access across multiple verticals.
• All diagnostics run through CLIA-certified Purity Labs (19,000 sq ft, Oregon).
• FDA guidance followed for Laboratory Developed Tests (LDTs), with transparent disclaimers.
• OSHA & DOT compliance for sample handling and biohazard transport (49 CFR, UN3373).
• Regular third-party proficiency testing and validation for quality assurance.
• Patient data hosted on Healthie, a HIPAA-compliant platform.
• Role-based access, audit logs, and end-to-end encryption across all systems.
• Subcontractors with PHI access sign Business Associate Agreements (BAAs).
• Secure portals for results, messaging, and appointments.
• Privacy policies aligned with HHS Notice of Privacy Practices (NPP).
• GDPR compliance roadmap and Canada/EU digital health import rules in progress.
• Manufactured in GMP-certified facilities.
• Registered under FDA DSHEA, with no unsubstantiated structure-function claims.
• Certificates of Analysis (COAs) issued for every batch.
• Mass spectrometry testing for heavy metals, pesticides, and microbial safety.
• Transparent QR-coded labeling with sourcing and toxin thresholds.
• Aligned with USDA Organic and Non-GMO Project standards.
• Fully compliant with California Prop 65 and EU reproductive toxicant exclusion rules.
• Nanobubble formulations backed by dermatology IRB documentation where required.
• CE marking and REACH compliance pathways scoped for export readiness.
• Multilingual packaging, COAs, and disclaimers prepared for global rollout.
• Manufactured under GMP and USDA Organic rules.
• Tested for heavy metals, pesticides, and contaminants via mass spectrometry.
• FDA “Closer to Zero” initiative standards followed.
• Transparent QR-linked traceability for every lot.
2i™ is designed to expand beyond private markets by aligning with public health priorities, equity initiatives, and institutional buyers. This dual strategy builds broad adoption, defensibility, and long-term contracts. Our public health initiatives extend P2i’s reach into underserved markets while generating institutional revenue streams. At the same time, they build brand trust, policy influence, and defensible ESG positioning—key differentiators for large-scale adoption and acquisition.
• Partnerships in progress with public health departments, Medicaid MCOs, and FQHCs.
• Bundled test + care packages offered at cost for county-level maternal health programs.
• Free sampling and test access distributed via mobile health clinics, community baby fairs, and nonprofit partners.
• Bilingual and culturally competent onboarding materials to ensure inclusion across diverse populations.
• Core education modules are designed to address toxicant exposure disparities in Black, Brown, and low-income communities.
• Directly aligned with HHS’s MAHA initiative specific to environmental health (Maternal and Infant Health and Environmental Awareness).
• Public webinars, media campaigns, and advocacy partnerships to raise awareness of overlooked exposures in high-risk zip codes.
• Policy collaboration with ACOG, AAP, and NAM via white papers and expert roundtables.
• Partnerships with maternal advocacy nonprofits to co-author campaigns and influence policy.
• Anonymized diagnostic data contributes to environmental health research and public health studies.
• Active participation in NIH-sponsored exposome databases and National Children’s Study cohorts.
• Offering bulk data licensing to academic and clinical institutions for maternal-child health research.
Q: What is the size of the P2i™ market opportunity?
A: P2i™ addresses a $250–300B global market across diagnostics, prenatal supplements, baby food, clean home/ personal care, and noninvasive medical testing. In the U.S. alone, the serviceable opportunity exceeds $1B within five years.
Q: What makes P2i™ different from other maternal-child health companies?
A: Most competitors are siloed - either genetic testing only, “clean” products without validation, or digital apps without clinical integration. P2i™ uniquely combines physician-led diagnostics, certified products, AI-guided care, and a longitudinal outcomes registry into one closed-loop platform. This structure creates a defensible moat that cannot be easily replicated.
Q: What prevents large incumbent players (e.g. Amazon, CVS, LabCorp, Nestlé) from copying the model?
A: Incumbents may replicate pieces, but none combines physician networks, NIH-modeled testing, certified products, and an auditable data registry. P2i’s network effects and longitudinal data advantage compound with scale, creating a barrier to entry.
Q: Why is the database so valuable compared to other medical datasets?
A: The P2i™ database links environmental exposures to high-cost health conditions such as autism, preterm birth, and ADHD. It is physician-entered, longitudinal, and focused on conditions costing $600B+ annually in the US.
Q: Why will providers adopt P2i™ now?
A: Regulatory momentum (FDA “Closer to Zero,” state heavy-metal bans), growing parental demand for transparency, and favorable economics for practices. Many doctors may increase income by 30–50% while delivering better outcomes.
Q: How is physician compensation structured?
A: Physicians earn from diagnostic testing, product margins, and participation in the medical database. The P2i™ business model rewards both clinical adoption and long-term engagement.
Q: How does P2i™ ensure testing accuracy and trust?
A: All diagnostics are conducted by Purity Laboratories, a CLIA- and ISO-certified facility recognized as an Agilent Center of Excellence. Testing protocols mirror NIH’s ECHO and PROTECT studies, ensuring the highest level of credibility.
Q: How do families experience the program?
A: P2i™ structures prevention into six stages: preconception pregnancy infancy toddler years early childhood school readiness Each stage includes diagnostics, guidance, certified products, and re-testing to measure outcomes.
Q: What role does AI play, and how is it different from telehealth platforms?
A: Docus.AI – integrated and customized by and for P2i™ -- interprets labs, predicts risk, and engages families with explainable insights. Unlike generic AI, it is trained on physician-entered, exposure-linked datasets, improving predictive accuracy as the database grows.
Q: How are consumer products validated?
A: Every P2i™ product - baby food, supplements, skincare, and home wellness - is mass-spectrometry tested, batchcertified, and linked to QR-coded Certificates of Analysis. The P2i™ Seal is a physician-trusted mark of safety and verification.
Q: How will you drive consumer adoption?
A: Distribution starts with OB-GYNs, pediatricians, and midwives, creating low-cost, high-trust adoption pathways. Consumer awareness is amplified through influencer campaigns, PR, and targeted retail once physician pathways are established.
Q: How much do families spend, and what is their ROI?
A: Families typically spend $20–25K over five years on P2i™ services and products. Preventing chronic conditions and complications yields up to a 10x+ ROI in avoided healthcare costs.
Q: What are the financial projections for investors?
A: Conservative case: Year 5 revenues of $400-$500 million with 45–50% gross margins. Upside case is $650 if provider adoption and institutional licensing accelerate. Database licensing may add $75–150M annually by Year 5.
Q: How capital-efficient is the model?
A: The $3m convertible notes cover CLIA automation, product inventory, and provider support. Positive cash flow is projected with multiple recurring, high-margin revenue streams.
Q: What are the key risks and mitigation strategies?
A: Physician adoption risk: mitigated by leadership credibility and turnkey onboarding. Family compliance risk: mitigated by AI personalization and proven engagement. Regulatory risk: mitigated by CLIA protocols and conservative claims. Competition risk: mitigated by first-mover advantage and data defensibility.
Q: How is compliance managed across diagnostics, supplements, and products?
A: Compliance is embedded in P2i™ from inception. Diagnostics are CLIA-certified; supplements follow FDA DSHEA; personal care complies with EU and California Prop 65 standards; data is HIPAA/GDPR protected. Auditready SOPs are maintained at all times.
Q : How scalable is the model internationally?
A: The model is designed for portability. Expansion begins in Southeast Asia (Philippines) using physician-society partnerships and IC-DISC tax advantages. Mexico and additional Asia markets follow once U.S. outcomes are documented.
Q: What are the exit opportunities for investors?
A: Strategic acquisition by a diagnostic, baby food, or supplement leader (LabCorp, Nestlé, Danone) is likely. Alternatively, IPO or SPAC routes are viable within 5–7 years if scale and growth are achieved.
Q: How will P2i™ manage rapid scaling of operations?
A: P2i’s operational framework combines automation, certified quality systems, and third-party scalability. Core infrastructure includes a CLIA-certified laboratory with automated processing, integrated Laboratory Information Management System (LIMS), and trusted 3PL partners providing nationwide pick-and-pack fulfillment. These thirdparty facilities collectively offer capacity to exceed 100,000 units per month, ensuring flexibility and speed as demand scales. All systems are engineered for high-volume, compliant growth, maintaining efficiency, traceability, and service reliability across channels.
Q: What is the long-term vision for P2i™?
A: To establish P2i™ as the gold standard in maternal-child care worldwide - where diagnostics, prevention, and certified products become the baseline of care. Over time, the P2i™ database and certification ecosystem will drive global public health, licensing, and research partnerships.
P2i™ is led by a multidisciplinary team with a track record in healthcare, diagnostics, wellness technology, and public health strategy. The leadership team and advisory board blend operational expertise, clinical credibility, and entrepreneurial acumen essential for scaling this movement.
David Humphrey is a seasoned entrepreneur, attorney, and environmental health leader with decades of experience in nonprofit strategy, regulatory law, and business innovation. He founded The Forum Institute and developed the P2i™ program to reduce pregnancy complications and chronic childhood disease through testing, clean products, and medical training.
David previously served as CEO of The Kirkman Group, building it into a nationally respected supplement company listed on NASDAQ. He also built Maui Gold and The Humphrey Corporation into national brands, showcasing his product development and operational strengths. As CEO of Purity Laboratories, he oversees advanced mass spectrometry testing for clinical and environmental toxins.
A top law school graduate and Mensa member, David, has deep expertise in legal compliance, product safety, and international expansion. He co-founded the Autism Treatment Network and MAPS and played a leadership role in the PIRG movement with Ralph Nader.
David combines public interest values with disciplined execution, making him the ideal leader to build P2i™ into a global platform for physician-led testing, clean baby products, and maternal-infant health solutions.
Dr. Jeanne Conry is a respected OB-GYN leader having served as the President of The International Federation of Gynecology and Obstetrics, the global society of OB-GYNs.
Formerly President of The American College of Obstetricians and Gynecologists, ACOG, she has shaped reproductive health policy for over 57,000 U.S. physicians. At P2i™, Dr. Conry ensures the scientific and clinical credibility of all programs, from prenatal supplements to clean-label cosmetics and environmental testing.
She leads curriculum development for physician training and sets global standards for product validation and patient care. Dr. Conry launched the U.S. National Maternal Health Initiative and chaired the Women’s Preventive Services Initiative (WPSI), which informs U.S. women’s health policy.
She is also President of the Environmental Health Leadership Foundation and a recipient of the EPA Health Champion Award. With both an MD and a PhD in biology, Dr. Conry merges clinical knowledge, research leadership, and public health expertise. Her role is essential to ensuring that the P2i™ program gains global trust, meets the highest standards, and improves outcomes across maternal and infant health. She has been awarded honorary fellowships in thirteen global obstetric and gynecology societies for her leadership. She served in a leadership position at Kaiser Permanente for over twenty years.
José F. Cordero, MD, MPH Senior Advisor, Government & Scientific Affairs | Board Member, The Forum Institute
Dr. José Cordero is a nationally acclaimed epidemiologist and public health leader. As former Director of the CDC’s National Center on Birth Defects and Developmental Disabilities and Assistant Surgeon General, he brings unmatched expertise in environmental health and birth outcomes.
At P2i™, he leads government engagement, oversees scientific validation of non-invasive testing, and directs the clinical outcomes database for tracking program impact. He helped pioneer NIH’s PROTECT study on prenatal exposure, which underpins P2i ™ 's testing approach.
Dr. Cordero also supports physician training and clinical publications to ensure rigorous evidence-based adoption. A former Chair of Epidemiology and Biostatistics at the University of Georgia, he is the Gordham L. and Virginia B “Jinx” Patel Distinguished Professor of Public Health. He has receive numerous awards from the America Academy of Pediatrics and the American Public Health Association for hislifetime scientific contributions. He has advised the CDC, NIH, and the World Health Organization on child health, nutrition, and reproductive health. His leadership positions P2i™ at the center of a scientific movement to reduce toxic exposures and prevent neurodevelopmental har. Dr. Cordero’s involvement provides critical credibility and alignment with public-sector priorities.
David Hoffman is a senior executive and Asia business strategist with over 30 years of experience in financial planning, market development, and international expansion.
As strategy lead at P2i™, David oversees planning and spearheads commercial growth across high-opportunity international markets including China, Singapore, Vietnam, Taiwan, and South Korea.
He previously served as Senior VP and Asia Director for The Conference Board, advising Fortune 500 CEOs on regulatory risk, strategic planning, and economic policy in China and Southeast Asia. For 21 years, he led PwC’s advisory practice in China, helping top-tier companies with market entry and financial structuring.
Fluent in Mandarin and a graduate in Chinese Studies from UC San Diego, he has served as an independent board director for public companies in Taiwan and Korea.
At P2I™, David will guide certification partnerships with Asian consumer brands, coordinate international sales initiatives, and ensure capital efficiency. His leadership provides the global strategy and operational rigor needed to scale the P2i™ initiative in international markets.
Travis Armstrong leads sales strategy, physician engagement, and national distribution at P2i™. He brings over a decade of direct experience implementing P2i, including product launches, doctor outreach, and multi-channel sales execution. As former National Sales Director at The Kirkman Group, Travis helped grow the company into a respected national brand, culminating in a NASDAQ listing.
He now serves as National Sales Director for Purity Laboratories, where he drives physician partnerships and test adoption for environmental and clinical testing. At P2i™, Travis oversees the national sales force, builds distribution channels, and manages implementation plans for certified physicians using P2i™ products.
His work includes integrating clean-label baby food, prenatal supplements, and non-invasive testing into practice workflows. He also develops distribution strategies for wellness programs and international markets.
With hands-on experience, strong physician relationships, and a record of scaling sales teams, Travis brings the energy and execution skills needed to commercialize P2i™ ™’s product and testing platform at scale.
Nathaniel
DeNicola, MD,
MSHP, FACOG Vice President of Medical Innovation and Strategic Communications | Board Member, The Forum Institute
Dr. Nathaniel DeNicola is a board-certified OB/GYN, FIGO Chair of Environmental Health, and leading media voice on maternal health and climate. At P2i™, he oversees physician portal development, testing infrastructure, and digital training tools while guiding communications strategy across media, policy, and medical networks.
He leads the P2i™ clinical outcomes database and contributes to physician certification content. As ACOG’s Chair of Telehealth and lead author of “Reducing Toxic Prenatal Exposures,” he has shaped national guidance on telemedicine and environmental risks in pregnancy. His research includes a landmark JAMA study linking pollution and adverse birth outcomes.
A former Robert Wood Johnson Scholar and Brookings Fellow, Dr. DeNicola is also affiliated with Johns Hopkins Health System and maintains a presence in Washington, DC. He has been featured in the New York Times, WSJ, Vogue, and The Weather Channel. At P2I™, he bridges public health science with digital innovation and public awareness, driving adoption through trust, credibility, and education.
Lee Grossman, MBA, ML
Director
of Strategic Alliances and Government & Advocacy Relations | Chairman of the Board, The Forum Institute
Lee has over 35 years of leadership in nonprofit health, medical devices, and disability advocacy. As Chair of The Forum Institute and Director of Strategic Alliances at P2i, he builds institutional partnerships across medical societies, public health agencies, and special needs organizations.
Lee is the current CEO of the Orthopedic Research and Education Foundation and former CEO of the Autism Society of America. In these roles he has led national coalitions, secured public funding, and influenced U.S. health policy. He also served on numerous federal agencies, committees, and non-profit boards and has presented at many congressional hearings and briefings and at the United Nations.
With over 20 years of medical device work in the Pacific Rim, Lee brings strong commercial and international experience. At P2i, he leads engagement with governments, disability networks, and global health leaders to promote the adoption of P2i-tested products and practices. His credibility with NIH, CDC, and advocacy groups ensures alignment with public health priorities and enhances visibility among clinical and consumer communities.
Director
Engagement | Faculty Leader, The Forum Institute
Dr. David Berger is a board-certified pediatrician with over 25 years of experience and more than 2,000 births under his care as he developed the clinical approach for P2i™.
He is the founder of Wholistic Pediatrics & Family Care in Tampa and a co-founder of MAPS (Medical Academy of Pediatric Special Needs), where he has trained hundreds of physicians in environmental and nutritional medicine. At P2i™, Dr. Berger leads physician onboarding, clinical training, and product integration, while overseeing the development and validation of certified products and testing standards. He also serves as senior clinical spokesperson for pediatricall P2i™ products and services.
Dr. Berger helped originate the international P2i™ initiative and continues to teach at medical conferences. His approach combines scientific rigor with personalized care, earning trust among physicians and families alike. His proven success in reducing pregnancy complications and improving child outcomes continues to drive nationwide awareness and adoption of the P2i™ model.
Bill O’Connor is a seasoned operational executive and serial entrepreneur with over four decades of leadership across healthcare, manufacturing, insurance, technology, and lobal expansion, while directing marketing strategy and investor engagement.
He is a long-time disciple of Neil Patel, applying data-driven frameworks to P2I™ ’s multi-channel brand and acquisition efforts. Mr. O’Connor’s track record includes Co-owning and operating a skilled nursing home chain for over a decade; Serving as a licensed securities broker focused on real estate syndications; Leading A-Angel Computers as President and COO; Executing a four-year turnaround of a 120-room hotel and casino in Costa Rica; Serving as President of Masterpiece Glass, overseeing manufacturing and multi-crew installations; Directing global marketing for Odorchem Manufacturing, expanding across three continents; Co-founding Paragon Processing, the largest hemp processing facility in
Beyond its core leadership, P2i™ is supported by an expanded network of scientific and strategic advisors representing pediatrics, environmental policy, hospital innovation, and digital health commercialization. This group brings together national and international experts — including leaders from major medical associations, healthcare systems, and health-tech ventures — who provide strategic guidance on clinical integration, regulatory alignment, and market expansion.
Their combined experience ensures that P2i™ maintains scientific integrity, operational scalability, and policy relevance as it grows. This advisory framework strengthens investor confidence by demonstrating that the company’s strategy is grounded in real-world practice, compliant with evolving health standards, and informed by professionals who have successfully navigated the path from research to market adoption.
the U.S., where he co-managed daily operations, led investment banking engagement, and oversaw sales and testing relationships.
Bill is also a partner in four companies strategically aligned with P2I™: Bolla Technologies: Nanobubble delivery systems for skincare and wellness; WCP Facility Solutions: Environmental wellness infrastructure and coatings; Wellness for Employees: HIPAA/IRS-compliant wellness reimbursement platform for employers; Trinks Consulting Group: Technical and regulatory compliance partner.
The P2i™ leadership team brings proven experience in building large - scale physician networks, clinical, and Real-World Evidence (RWE) databases. The Forum Institute created the Autism Treatment Network (ATN), mobilizing practicing physicians to generate high -value clinical data.
Dr. José Cordero designed and analyzed longitudinal maternal - child datasets as architect of NIH’s PROTECT studies - the very research that informs P2i™. The MAPS network further demonstrates our capacity to engage thousands of clinicians in data collection and improvement initiatives.
1. Characteristics of Autism Spectrum Disorder Among Children Aged 8 Years—Autism and Developmental Disabilities Monitoring Network, 11 Sites, United States, 2020. MMWR Surveill Summ. 2023;72(2):1-14.
doi:10.15585/mmwr.ss7202a1.Shaw KA, Williams S, Patrick ME, et al. Prevalence and Early Identification of Autism Spectrum Disorder Among Children Aged 4 and 8 Years - Autism and Developmental Disabilities Monitoring Network, 16 Sites, United States, 2022. MMWR Surveill Summ. 2025;74(2):1-22. Published 2025 Apr 17. doi:10.15585/mmwr.ss7402a1
Quote : “Overall, ASD prevalence was 32.2 per 1,000 (one in 31) children aged 8 years.”
2. Centers for Disease Control and Prevention. Most Recent National Asthma Data. Updated November 2024 . Accessed November 2025. https://www.cdc.gov/asthma/most_recent_national_asthma_data.htm
Quote: “Current asthma prevalence is 6.2% among children under 18 years.”
3. Jackson KD, Howie LD, Akinbami LJ. Trends in Allergic Conditions Among Children: United States, 1997–2011. NCHS Data Brief. 2013;(121):1-8. https://www.cdc.gov/nchs/products/databriefs/db121.htm
Quote: “In 2021, 5.8% of children under age 18 years had food allergies.”
4. American College of Obstetricians and Gynecologists (ACOG). Early Pregnancy Loss. ACOG Practice Bulletin No. 200. Obstet Gynecol. 2018;132(5):e197-e207.
Quote: “Early pregnancy loss is common, occurring in 10% to 20% of clinically recognized pregnancies.”
5. Martin JA, Hamilton BE, Osterman MJK, Driscoll AK. Births: Final Data for 2021. Natl Vital Stat Rep. 2023;72(1):1-50.
Quote: “In 2021, the preterm birth rate rose to 10.49%, meaning approximately 1 in 10 infants was born preterm.”
6. Centers for Disease Control and Prevention. Stillbirth Data and Statistics. Updated 2023.Accessed August 2025. https://www.cdc.gov/stillbirth/data-research/index.html
Quote: “Stillbirth affects about 1 in 175 births in the United States.”
7. National Institute of Diabetes and Digestive and Kidney Diseases (NIDDK). Celiac Disease: Definition and Facts. Updated 2020. Accessed August 2025.https://www.niddk.nih.gov/health-information/digestive-diseases/ celiac-disease/definition-facts
Quote: “Celiac disease affects about 1 in 100 people worldwide, including about 1% of the U.S. population.”
8. Centers for Disease Control and Prevention. Attention-Deficit/Hyperactivity Disorder (ADHD) Data and Statistics. NHIS 2020–2022. Accessed August 2025. https://www.cdc.gov/nchs/data/databriefs/db499.pdf
Quote: “From 2020–2022, 11.3% of children aged 5–17 years had ever received a diagnosis of ADHD.”
9. Blank R, Barnett AL, Cairney J, et al. International clinical practice recommendations on the definition, diagnosis, assessment, intervention, and psychosocial aspects of developmental coordination disorder. Dev Med Child Neurol. 2019;61(3):242–285.doi:10.1111/dmcn.14132.
Quote: “Developmental coordination disorder affects approximately 5–6% of school-aged children, with around 2% severely affected.”
10. Merikangas KR, He J, Burstein M, et al. Lifetime Prevalence of Mental Disorders in U.S.Adolescents: Results from the National Comorbidity Survey Replication–Adolescent Supplement (NCS-A). J Am Acad Child Adolesc Psychiatry. 2010;49(10):980-989. doi:10.1016/j.jaac.2010.05.017.
Quote: “The lifetime prevalence of bipolar disorder among adolescents aged 13–18 years was 2.9%.”
11. Fryar CD, Carroll MD, Afful J. Prevalence of Overweight, Obesity, and Severe Obesity Among Children and Adolescents Aged 2–19 Years: United States, 1963–1965 Through 2017–2018. NCHS Health E-Stats. 2020. https://www.cdc.gov/nchs/data/hestat/obesity- child-17-18/obesity-child.htm
Quote: “The prevalence of obesity among U.S. youth aged 2–19 years was 19.7% in 2017–2020.”
12. American Childhood Cancer Organization (ACCO). Childhood Cancer Statistics.Accessed August 2025. https://www.acco.org/us-childhood-cancer-statistics
Quote: “Approximately 1 in 285 children in the United States will be diagnosed with cancer before their 20th birthday.”
13. American Cancer Society. Key Statistics for Childhood Leukemia. Updated 2024. Accessed August 2025. https://www.cancer.org/cancer/types/leukemia-in-children.html
Quote: “Leukemia is the most common cancer in children and teens, accounting for about 28% of all cancers in those younger than 20.”
4 Appendix J – “Baby & Toddler Foods – Establishing a New Standard in Nutritional Purity and Safety” –defines P2i’s sourcing standards, formulation integrity, and packaging protocols, etc.
5 Appendix G – Nanobubble Personal Care Line – provides a full product line description, plan and applicable scientific backing.. 6 Appendix F – Advancing Healthy Home Environments Through Integrated Product and Service Solutions – provides full product line description, plan and science.
7 Appendix F1 – “Safe Home Air and Surface Protection” – provides a full overview of the science and crossprotective mechanisms supporting this product category.
8 Appendix K – “Safe Infant Textiles and Global Standards Framework” – provides further details, design concepts, and data supporting this product line.
9 Appendix C – White Paper – Advancing Public Health Through Non-Invasive Toxicity Testing . Purity Laboratories is the designated testing partner for P2i and will serve as the primary laboratory for both clinical and public health deployments.

P2i™ protects moms and babies from toxic chemicals. Tested products – Trusted solutions
P2i™ protects moms and babies from toxic chemicals.

Tested products – Trusted solutions